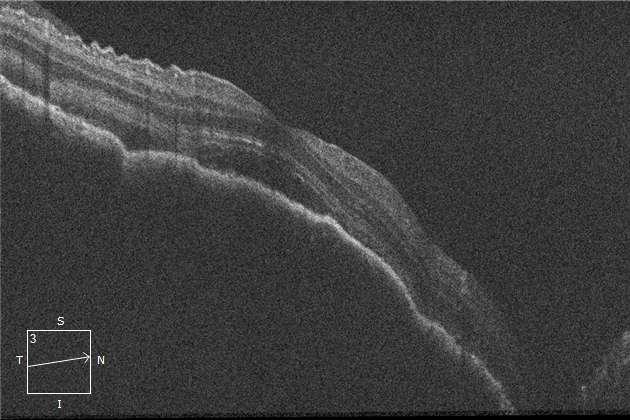
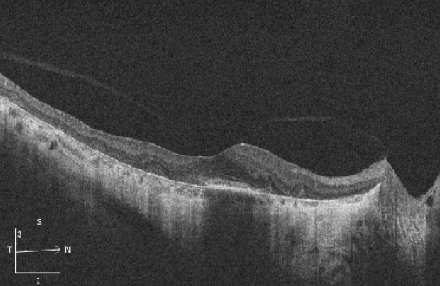
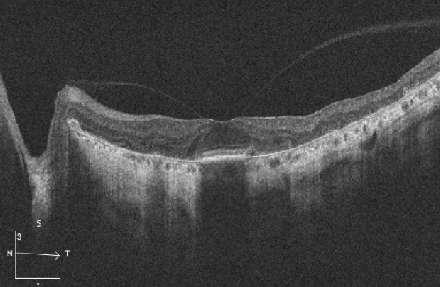

Dra. María José Vergara de Caso
Dra. Isabel Cavieres Cárdenas
Dr. Álvaro Rodríguez Vega
Dr. Cristian Sánchez Mora
Dr. Rodrigo Donoso Rojas
• La ”Fototeca Salvador” comenzó como una actividad dirigida a residentes de Oftalmología del Hospital del Salvador, los cuales a través de imágenes obtenidas de su hospital describían y discutian diagnósticos diferenciales en reuniones clínicas establecidas.
• Por lo interesante que resultó este ejercicio, me motivé a publicar la primera edición de este atlas, cuyo propósito es orientar a los residentes en la semiología y diagnóstico a partir de imágenes de las distintas enfermedades oftalmológicas.
• Este atlas a color suma más de 300 imágenes, todas de gran calidad y ordenadas según criterio estrictamente clinicos.
• El atlas se divide en 4 partes, las cuales a su vez estan conformadas por capítulos dentro de cada subespecialidad.
• La primera parte esta conformada por imágenes de ”Polo anterior”, seguido por “Polo posterior”, “Órbita” y finalmente“Trauma”. Esta última parte cobra especial importancia al tener nosotros como hospital la “Unidad de trauma ocular”, la cual es centro de derivación nacional por lo que constantemente estamos sometidos a diversos desafíos diagnósticos y terapéuticos.
• Las imágenes de cada capítulo incluyen información útil, descripción, y/o casos clínicos para complementar.
• A futuro queremos lograr que sea un ”Atlas interactivo” por lo que se invita a todos a aportar imágenes, dado que cada 6 meses se realizará una evaluación de lo obtenido por parte tanto de los staff como residentes, a partir de lo cual eligiremos la mejor imágen por especialidad, así como también la mejor de todas.
• Por último quiero agradecer el arduo trabajo de recopilación de imágenes lo cual ha sido gracias al gran aporte por parte de los residentes y Staff y también a la incorporación de contenidos en la cual ha participado la Dra. Isabel Cavieres, Dr. Ávaro Rodríguez, Cristián Sanches, Dr. Donoso y yo (Dra. María José Vergara).
Dra. María José Vergara de Caso
• Residente de Oftalmología
• Departamento de Oftalmología del Hospital del Salvador
• Universidad de Chile
• Santiago, Chile.
Dra. Isabel Cavieres Cárdenas
• Residente de Oftalmología
• Departamento de Oftalmología del Hospital del Salvador
• Universidad de Chile
• Santiago, Chile.
Dr. Álvaro Rodriguez Vega
• Profesor asistente de la Universidad de Chile de Oftalmología
• Departamento de Oftalmología del Hospital del Salvador
• Universidad de Chile
• Santiago, Chile.
Dr. Cristian Sánchez Mera
• Fellow de Oftalmología Pediatrica y Estrabismo el Hospital Calvo Mackena
• Oftalmólogo del Hospital del Salvador
• Departamento de Oftalmología del Hospital del Salvador
• Universidad de Chile
• Santiago, Chile.
Dr. Rodrigo Donoso Rojas
• Profesor titular de la Universidad de Chile de Oftalmología
• Departamento de Oftalmología del Hospital del Salvador
• Universidad de Chile
• Santiago, Chile.
• ADV: Adenovirus
• AV: Agudeza Visual
• A-V: Arterio venosa
• BMC: Biomicroscopía
• BPES: Síndrome Blefarofimosis-Ptosis-Epicanto inverso
• CA: Cámara Anterior
• CAE: Con Agujero Estenopeico
• CC: Con corrección
• CE: Cuerpo extraño
• CEC: Carcinoma Escamoso de la Conjuntiva
• CEIO: Cuerpo Extraño Intraocular
• CHRPE: Hipertrofia Congénita del Epitelio Pigmentario
• CIN: Neoplasia Intraepitelial Conjuntival
• CMV: Citomegalovirus
• CRE: Coriorretinopatía esclopetaria
• DCEF: Distrofia Endotelial de Fuchs
• DEP: Desprendimiento del Epitelio Pigmentario
• DMRE: Degeneración Macular Relacionada a la Edad
• DPAR: Defecto Pupilar Aferente Relativo
• E: Estadío
• EP: Edema de Papila
• EPR: Epitelio Pigmentario Retinal
• FAP: Poliposis Adenomatosa Familiar
• FO: Fondo de Ojo
• H: Hombres
• HDS: Hospital del Salvador
• HIC: Hipertensión Intracraneana
• HPO: Herida Penetrante Ocular
• HTA: Hipertensión arterial
• LIO: Lente Intraocular
• LMP: Luz Mala Proyección
• M: Mujeres
• MD: Membrana de Descemet
• MFNR: Mielinización de Fibras Nerviosas Retinales
• MNVC: Membrana Neovascular Coroidea
• NO: Nervio Óptico
• NPL: No Proyecta Luz
• NRA: Necrosis Retinal Aguda
• OACR: Obstrucción de la Arteria Ciliorretinal
• OCT: Tomografía de Coherencia Óptica
• OD: Ojo Derecho
• ODI: Ojo Derecho e Izquierdo
• OI: Ojo Izquierdo
• OTS: Puntuación de trauma ocular (ocular trauma score)
• PAF: Poliposis Adenomatosa Familiar
• PEX: Pseudoexfoliación
• PIO: Presión Intraocular
• PK: Precipitados Queráticos
• PUK: Queratitis Ulcerativa Periférica
• QMT: Quimioterapia
• QPB: Queratopatía en Banda
• RAM: Reacción adversa a medicamento
• RH: Retinopatía Hipertensiva
• RNM: Resonancia Nuclear Magnética
• SAPU: Servicio de Atención Primaria de Urgencia
• SAR: Síndrome de Axenfeld-Rieger
• SBPEI: Síndrome de blefarodimosis–ptosis-epicanto inverso
• SC: sin corrección
• SD: Síndrome
• TC/ TAC: Tomografía Axial Computarizada
• TVCR: Trombosis de Vena Central de la Retina
• UGH: Síndrome de Uveitis-Glaucoma-Hifema
• UTO: Unidad de Trauma Ocular
• USEIR: Eegistro de lesiones oculares de Estados Unidos
• VH: Van Herick
• VHS: Virus Herpes Simple
A. Granuloma piógeno
B. Papiloma conjuntival
C. Melanoma conjuntival
2. HIDROPS CORNEAL
3. DISTROFIAS CORNEALES
A. Distrofia granular
B. Distrofia endotelial de fuchs
C. Distrofia de la membrana basal del epitelio.
A. Queratopatia en banda
B. Rosácea ocular + perforación corneal
C. Rosácea ocular
5. AFECCIONES INFLAMATORIAS Y DEGENERATIVAS DEL LIMBO CORNEAL
A. Degeneración marginal de terrien
B. Queratitis ulcerativa periferica
C. Queratitis ulcerativa periférica + descematocele
D. Queratitis ulcerativa periférica
6. PATOLOGÍA INFECCIOSA
A. Infiltrados subepiteliales por ADV
B. Queratitis herpética epitelial por VHS
C. Queratitis disciforme
D. Queratitis inmune estromal herpética
E. Queratopatía cristalina (S. viridans)
F. Úlcera por pseudomona
G. Úlcera por pseudomona
H. Úlcera corneal por hongo filamentoso
I. Úlcera corneal por fusarium SPP
J. Absceso corneeal con descematocele
A. Aniridia esporádica + catarata congénita
B. Catarata lamelar
C. Catarata + Atrofia esencial del iris + zonulodiálisis
A. Uveitis aguda bilateral anterior no granulomatosa
B. Uveitis anterior unilateral herpética
C. Sd. Uveitis – Glaucoma – Hifema
A. Estrías de Haab
B. Glaukomflecken
C. Síndrome de Axenfeld Rieger + Glaucoma secundario
A. Silicona en cámara anterior emulsificado
B. Subluxación lente intraocular secundario a Sd. De Vogt


Bü Lesión pedunculada y aspecto papilomatoso de color sonrosado que se desarrolla después de un trauma quirúrgico, accidental o un proceso inflamatorio local (chalazión o reacción a cuerpo extraño)
ü EL diagnóstico diferencial debe realizarse principalmente con un papiloma pediculado, con el que generalmente le diferencia la velocidad de progresión y el antecedente de traumatismo o chalazión.



ü Imágenes A, B y C muestran papiloma escamoso conjuntival en conjuntiva inferonasal de ojo derecho
ü Lesion benigna
ü Se presentan como lesiones exofíticas, de color sonrosado, de consistencia blanda y superficie irregular.
ü Pueden ser de etiología viral (papilomavirus humano), y en este caso pueden recurrir.
ü Tienden a ser pedunculados en niños (más frecuentes en fórnix inferior) y sésiles (más frecuentes en conjuntiva bulbar) en adultos.
ü Suelen ser asintomáticos, sin signos inflamatorios asociados.
ü Clínicamente pueden ser difíciles de distinguir de lesiones precancerosas y carcinomatosas.
ü Mujer 23 años refiere que desde hace 5 años tiene un solevantamiento de color oscuro en polo anterior del ojo derecho, sin embargo los últimos 3 años ha tenido un crecimiento acelerado de la lesión. Refiere que el mayor crecimiento ocurrió relacionado al embarazo.




AImagen A y B: Lesión solevantada, irregular y pigmentada a nivel limbar nasal, que se proyecta hacia la cornea cubriendo parcialmente el eje visual. Lesión asociada a vaso centinela.
Imagen C y D: Tumoración conjuntival epicorneal en sector nasal y limbar, pigmentado, de 6.46mm de diámetro Meridional y 1.18 mm de espesor, que no compromete ángulo y tampoco iris. No hay compromiso del cuerpo ciliar. Su estructura acústica es homogénea y su reflectividad intermedia, sugerente del diagnóstico de un melanoma conjuntival y epicorneal. B


Epidemiología
ü 2% de todas las neoplasias oculares
ü Incidencia en occidente: 0.2 y 0.5 en casos por 1 millón de habitantes (en aumento)
ü Tasa de incidencia anual ajustada por edad: 0.33 en los hispanos, y 0.49 een la población blanca no hispana
Manifestaciones clínicas
ü Lesión conjuntival pigmentada nodular o plana
ü Tumores amelanóticos pueden confundir el cuadro clínico y retrasar el diagnóstico
ü Pueden afectar cualquier parte de la conjuntiva incluyendo limbo, fornix bulbar, conjuntiva palpebral, y la cornea
ü Signos clínicos: pigmento conjuntival en su periferia o en la lesión misma, vascularización, vaso nutricio prominente y engrosamiento progresivo de lesión plana.
Histología
ü De novo (peor pronostico)
ü Nevo preexistente (presentarse en la infancia y el aumento de tamaño en un adulto deben aumentar la sospecha de transformación maligna).
ü Melanosis adquirida primaria con atipia.
Factores de riesgo de recurrencia
Pigmentación irregular
Factores de riesgo de metástasis
Factores de riesgo para mortalidad
Grosor tumoral >2.0mm Ubicación en la conjuntiva palpebral, carúncula, plica o fórnice
Extirpación quirúrgica incompleta Ulceración
Invasión tumoral más profunda que la sustancia propia
Ubicación de Nonepibulbar
Grosor del tumor
Figura mitótica >1/mm2 Invasión tumoral más profunda que la sustancia propia
Recurrencia local
Márgenes positivos del tumor Surgiendo de novo
Tipo de célula epitelióide
Invasión linfovascular
Ubicación Extralimbal MIcrosatellitosis
Linfangiogénesis asociada al tumor Linfanfiogénesis asociada al tumor Linfangiogénesis asociada al tumor
Excisión sola como terapia inicial
Shields, C. L., Kaliki, S., Al-Dahmash, S. A., Lally, S. E., & Shields, J. A. (2012). American Joint Committee on Cancer (AJCC) Clinical Classification Predicts Conjunctival Melanoma Outcomes. Ophthalmic Plastic and Reconstructive Surgery, 28(5), 313–323. doi:10.1097/iop.0b013e3182611670
Surgiendo de novo
Recurrencia local
Edad >55 años
Diagnóstico diferencial de las lesiones melanocíticas conjuntivales benignas
Nevo benigno
Melanosis primaria adquirida
Nevus azul de la conjuntiva
Carcinoma escamoso conjuntival pigmentado
Queratosis seborreica conjuntiva
Extensión extraocular del melanoma uveal
Quiste hemático posquirúrgico
Prolapso uveal a través de la herida quirúrgica
Quiste de inclusión conjuntival
Granuloma piógeno necrótico
Micosis conjuntival
Granuloma de cuerpo extraño de grafito de lesión por lápiz
Argirosis exógena
Mascaroma conjuntival
Cuerpos extraños conjuntivales (mullita e ilita)


Bü También conocida como hidropesía aguda, ocurre por una rotura de la membrana de Descemet, permitiendo la entrada aguda y súbita de humor acuoso en el espesor corneal, provocando edema. A
ü Se presenta de forma aguda con dolor disminución de la agudeza visual y fotofobia.


ü Paciente de 9 años con antecedentes de síndrome de down consulta en unidad de trauma ocular por disminución de la agudeza visual.
ü Al examen físico se evidencia en ojo derecho (imágenes A, B, C y D):
ü Hiperemia conjuntival
ü Edema corneal marcado con engrosamiento estromal, presencia de bullas estromales y subepiteliales asociado a opacidades lineales verticales.
ü Protrusión y deformidad cónica central con adelgazamiento corneal sobre borde paplpebral
ü Hendidura en forma de V en parpado inferior (signo de munson).
ü Tras la resolución del edema corneal queda una cicatrización estromal de grado variable.



ü Mujer 60 años consulta por disminución de la agudeza visual bilateral. Al examen físico presenta opacidades grises en el estroma superficial central de la cornea y en la membrana de bowman (imágenes A, B y C).
ü Las distrofias corneales son enfermedades raras, dentro de ellas las estromales tienen baja incidencia.
ü La distrofia granular es una enfermedad autosómica dominante.
ü Se caracteriza por ser de presentación bilateral y asimétricaü Las alteraciones se hacen visibles en la primera y segunda décadas de la vida, lo que provoca una disminución de la visión más significatica cerca de los 40 años de edad.
ü A la biomicroscopía se pueden observar opacidades grises en el estroma superficial central de la cornea y en la membrana de bowman.
ü El material encontrado en el estroma es de tipo queratohialino y puede ser producido por queratocitos anómalos.
ü El estudio de la historia familiar nos ayuda en el correcto diagnóstico y la biomicroscopia constituye el elemento más importante.



Cü Trastorno degenerativo específico y progresivo del endotelio corneal, donde la membrana de descemet (MD) puede estar muy afectada con engrosamiento y excrecencias posteriores denominadas clínicamente gutas.
ü Mujer de 60 años refiere que hace 6 meses presenta disminución de la agudeza visual que es más marcada al despertar. Al examen físico destacan guttas en la membrana de descemet del ojo derecho (Imagen A, B y C).
ü Al producirse discontinuidades en el endotelio fallan su función de barrera y actividad de sus bombas iónicas, lo que crea una insuficiencia en la resorción de fluidos y acumulación de agua en la córnea, con todo el cortejo sintomático consecuente.
ü La DCEF afecta al 4% de la población mayor de 40 años, y más a mujeres que a hombres. La mayoía de los casos es de transmisión autosómica dominante.
ü Estadío (E) clínico de la DCEF:
-E I: cambios sólo biomicroscópicos, con córnea guttata central, pigmentación endotelial variable y engrosamiento de la MD. Al progresar, toma aspecto de “metal batido”.
-E II: disminución visual indolora, más marcada al despertar, descrita como “neblina” (edema epitelial), desaparece a lo largo del día o puede quedarse como un fino velamiento grisaceo central. Microquistes epiteliales.
-E III: aparición de quistes y vesículas (bulas) epiteliales y subepiteliales, miccroscópicas y macroscópicas. Edema estromal central o paracentral, en forma de vidreo esmerilado. Estrías y pliegues en la MD.
-E IV: cicatrización subepitelial con marcada disminución de la visión y dolor, menor edema, puede desarrollar neovascularización superficial. Vesículas “enquistadas”. Fibrosis subepitelial hipertrófica con apariencia de queloides. A B



ü Es la distrofia corneal anterior más común, frecuente en adultos del sexo femenino, entre 40-70 años de edad.
ü La mayoría de los casos son esporádicos no hereditarios, en caso de ser hereditaria se transmite a través de un patrón autosómico dominante.
ü Generalmente asintomática, sin embargo alrededor del 10% de los pacientes desarrollan erosiones corneales epiteliales recurrente.
ü Cambios microquísticos en forma de opacidades blanco – grisáceas, pequeñas ovales, alargadas e irregulares en el epitelio corneal de esta afección.
ü Pueden presentar tres formas de presentación en forma aislada o combinada:
-Patrón en mapa: líneas geográficas, grises, irregulares
-Huellas dactiles: líneas delgadas concéntricas o curvilíneas que se observan mejor por retroiluminación
-Punto: quistes pequeños redondos
ü Otro patrón menos usual descrito como cambios en bula que se observan mejor en la transiluminación.

ü Imagen A: Cambios microquísticos en forma de opacidades blanco –grisáceas, pequeñas ovales, alargadas e irregulares en el epitelio corneal de esta afección.

ü Imagen B: “Patrón en mapa”: líneas geográficas, grises e irregulares
Caso

ü Mujer, 60 años, desde los 10 años con QPB, de origen idiopática

ü Imágenes A, B, C y D: depósitos blanquecinos en espacio subepitelial y parte anterior de la membrana de bowman.


ü Alteración degenerativa corneal que se caracteriza por el depósito de sales de calcio en el espacio subepitelial y en la parte anterior de la membrana de bowman.
ü Aparece una opacidad en banda horizontal de aspecto blanquecino-grisáceo, que crece de la periferia corneal hacia el centro y siempre conserva una zona transparente que la separa del limbo esclero corneal.
ü Etiología:
1.Primarias: Idiopática.
2.Secundarias:
-Origen ocular: enfermedades crónicas (glaucoma avanzado, uveítis,queratitis crónica grave, aceite de silicona en cámara anterior, ojo seco, medicaciones tópicas, etc).
-Origen metabólico o sistémico: calcificación metastásica, hiperuricemia, insuficiencia renal crónica, hipercalcemia por sarcoidosis, artritis reumatoide juvenil (triada de still), hiperparatiroidismo, o exposición a tóxicos de mercurio.


Bü Hombre 50 años con antecedentes de rosácea amanece con ojo rojo y dolor ocular leve, asociado a disminución de la agudeza visual (AV), por lo que decide consultar en el SAPU siendo derivado al servicio de oftalmología del Hospital de Arica. Ante la gravedad de cuadro lo derivan al policlínico de choque del Hospital del Salvador.
ü El mismo día se decide comenzar tratamiento con doxiciclina oral y colocar parche de cianocrilato en pabellón, sin embargo al control del día siguiente el parche se había desplazado hacia el fornix superior.
ü Por lo anterior se decide hospitalizar y colocar parche de esclera.
ü Por dolor articular referido por el paciente se solicitan exámenes reumatológicos (ANA y FR) que resultan negativos y se realiza interconsulta a reumatología en su hospital de base.
ü Ante la solicitud del paciente se da el alta y paciente continúa sus controles en la ciudad de Arica.


Bü Signos:
ü La rosácea es una enfermedad crónica y acneiforme de la piel, clasificada anteriormente dentro del grupo de las enfermedades seborreicas.
ü Es más frecuente en mujeres, siendo la relación mujerhombre que va del 2:1 al 3:1.5,7.
ü La edad de presentación inicial de la rosácea se sitúa entre la tercera y quinta décadas de la vida, con una prevalencia hasta del 10%.
ü Cerca del 60% de los pacientes presentan manifestaciones oculares, ocurriendo alteraciones corneales en hasta un 33% de ellos.
ü La rosácea ocular puede permanecer desapercibida por mucho tiempo, ya que se estima que el 53% de los pacientes con involucro ocular manifiestan signos cutáneos precedentes. Por otra parte, es importante destacar que el 20% inician con síntomas oculares antes de desarrollar lesiones en la piel y un 27% de los pacientes desarrollan ambas afecciones de manera simultánea.
ü Síntomas:
- Ardor ocular, dolor ocular agudo, punzante y transitorio y sensación de sequedad
- Sensación de CE que empeora en las mañanas
- Fotobia y lagrimeo que empeoran con la luz intensa
- Visión borrosa fluctuante.
- Inflamación crónica del margen palpebral anterior y posterior, formación de escamas y collarines alrededor de las pestañas
- Disfunción de glándulas de meibomio
- Chalazion recurrente
- Hiperemia conjuntival y conjuntivitis papilar
- Secreción espumosa, película lagrimal excesivamente oleosa y en ocasiones con partículas de mucina
- Inestabilidad de la película lagrimal con tiempos de ruptura acortados y reducción del volumen lagrimal
- Infiltrados redondos en cornea limbar, pequeños, que se extienden centralmente.
- Adelgazamiento corneal
- Vascularización superficial
- Úlceras, perforaciones corneales
Patiño Ramírez, B.E., Rodríguez García,A., Díaz, J.C., & Ávalos, Y.P. (2012). Alteraciones de La Superficie Ocular En Pacientes Con Rosácea Ocular. Revista Mexicana de Oftalmologia, 86(2), 86?96.
Aal Aarfaj K, Al Zamil W. Spontaneous corneal perforation in ocular rosacea. Middle East Afr J Ophthalmol. 2010 Ap-Jun; 17(2): 186-188.
Boyd Kierstan, Mendoza Odalys. Ocular rosacea. American academy of ophthalmology. Sep 9, 2022.

ü Hiperemia e inyección conjuntival
ü Cámara anterior estrecha, VH1
Bü Adelgazamiento corneal
ü Defecto epitelial con perforación corneal
ü Vascularización superficial
ü Vascularización superficial
ü Brillo corneal alterado
ü Opacificación central

ü Hombre 67 años consulta por cuadro de 2 años de evolución de dolor ocular y disminución de la agudeza visual. Refiere estar usando desde hace 1 año Loteprednol tópico.


ü Hiperemia e inyección conjuntival
ü Neovascularización estromal
ü Telangectasias
ü Pannus en 360º
ü Opacidad corneal + neovasos estromales
ü Telangectasias



ü Se caracteriza por un adelgazamiento marginal de la cornea.
Epidemiología
ü Hombres, niños a adultos mayores, la mayoría <30 años
ü Es bilateral pero asimétrico
Clínica
ü Adelagazamiento corneal progresivo que comienza superiormente con una excavación periférica con un infiltrado lipídico en un borde central y vascularización en su base.
ü Excavación periférica con un infiltrado lipídico en un borde central y vascularización en su base A B
ü El epitelio que lo cubre está siempre intacto por lo tanto no teñiría con Fluoresceína (NO ES UNA ÚLCERA).
ü Enfermedad de curso lento y progresivo sin afectación de la cornea central por lo que el pronóstico en general es bueno.
ü En algunas ocasiones el adelgazamiento se asocia con inflamación recidivante, epiescleritis o escleritis.
ü La vascularización superficial condiciona un adelgazamiento corneal y ectasia corneal, que produce astigmatismo y disminución de la agudeza visual.
Diagnóstico diferencial
ü Principal diferencial es con la úlcera de Mooren
ü Hombre de 25 años con úlcera marginal de Terrien en ambos ojos demostrado en las imágenes A, B y C.
ü Hiperemia e inyección conjuntival



ü La queratitis ulcerativa periférica es una inflamación y ulceración de la córnea.
ü A menudo aparece en enfermedades del tejido conjuntival autoinmunitarias, activas o de larga evolución, como la artritis reumatoide (causa más frecuente en los pacientes con PUK con una prevalencia de un 34-42%), granulomatosis con poliangeítis (antes denominada granulomatosis de wegener) y policondritis recidivante.
ü Con frecuencia presentan disminución de la agudeza visual, fotofobia y sensación de CE.
ü Clínicamente se caracteriza por una opacificación semilunar en la periferia corneal debido a un infiltrado con leucocitos.
ü La ulceración se desarrolla poco después de la opacificación. Esta manifestación se opone a la úlcera infecciosa habitual, que comienza con una solución de continuidad epitelial y más tarde desarrolla opacificación.
ü Deben descartarse causas infecciosas como bacterias, hongos y virus herpes simple mediante el cultivo de la úlcera y los bordes palpebrales.
ü Hiperemia e Inyección conjuntival
ü Opacificación semilunar en la periferia corneal debido al infiltrado con leucocitos.


ü Opacificación semilunar en la periferia corneal debido al infiltrado con leucocitos.
ü Conjuntiva hiperemica

ü Mujer 73 años con antecedentes de lupus eritematoso sistémico y Sd. Sjogren consulta por cuadro de 3 semanas de evolución de dolor ocular, ojo rojo y epífora asociado a disminución de la AV.

ü Imágenes A, B y C muestran compromiso ojo derecho con queratitis ulcerativa periférica.

Imágenes aportadas por Dr. Nathan Dukes


ü
ü Queratitis ulcerativa periférica en paciente con artritis reumatoide. A B
Opacificación semilunar en la periferia corneal debido al infiltrado con leucocitos.
ü Conjuntiva hiperemica
ü Tinción con fluoresceína +



ü La queratoconjuntivitis epidémica por adenovirus se caracteriza por la presencia de infiltrados corneales subepiteliales multifocales los cuales aparecen alrededor de los 7-14 días de inicio de los síntomas oculares (Imagen A, B y C).
ü Su localización es a nivel estromal.
ü Estos se deben probablemente, a una respuesta inmunopatológica, a la infección vírica de queratocitos en el estroma corneal superficial. A B

ü La Infección ocular por VHS es generalmente unilateral ü Autolimitada
ü Alta tasa de recidiva.
ü Presenta áreas de queratitis epitelial puntiforme que pueden coalescer en una o más úlceras epiteliales dendríticas arborescentes con bulbos terminales al final de cada rama. El epitelio corneal citopático tumefacto del borde de la úlcera herpética se tiñe con rosa bengala y verde lisama. El lecho de la úlcera se tiñe con fluoresceína. Las areas de queratitis dendríticas pueden coalescer aún más y aumentar de tamaño formando una úlcera epitelial geográfica más expansiva.
ü Tienen hiperemia ciliar e inyeccción conjuntival leve.
ü Debajo de la queratitis epitelial puede haber edema leve del estroma e infiltrado subepitelial con leucocitos.
Imágenes aportadas por Dr. Osvaldo Weisse

ü Imagen A y B muestra úlceras epiteliales dendríticas arborescentes con bulbos terminales al final de cada rama.


ü Brillo corneal no conservado.
ü Úlceras epiteliales dendríticas arborescentes con bulbos terminales al final de cada rama.
ü Tienen hiperemia ciliar e inyeccción conjuntiva.
ü El lecho de la úlcera se tiñe con fluoresceína.




ü Es una endotelitis primaria que se presenta como edema del estroma corneal y edema epitelial en una distribución redonda u ovalada, asociado a precipitados retroqueráticos bajo la zona de edema.
ü Puede haber iridociclitis asociada y la queratitis disciforme se puede confundir con uveítis con descompensación secundaria del endotelio corneal. No obstante, en la queratitis disciforme encontramos un edema disciforme estromal y precipitados retroqueráticos desproporcionados al grado de reacción de la camara anterior.
ü Las queratitis disciformes debidas a VHS y a VHZ son clínicamente indistinguibles.

ü Mediado por antígeno (complemento anticuerpo), posiblemente por retención de antígeno viral dentro del estroma ü 20-25% de los pacientes con enfermedad ocular herpética hacen queratitis estromal ü Se caracterisa por:
- Hiperemia conjuntival
- Flush ciliar
- Reacción camara anterior,
- Epitelio suprayacente casi siempre intacto (excepto cuando se combina con enfermedad epitelial)
- Infiltracion estromal, opacidad punctata estromal
- Anillo inmune
- Edema
- Limbitis
ü Puede evolucionar (lo que observamos en este caso)
- Adelgazamiento corneal
- Cicatrizacion corneal
- Neovascularización en cualquier nivel de la cornea, vasos fantasmas
- Depositos de lipidos
ü Paciente 65 años con antecedentes de 2 episodios de de queratiopatía herpética.

Bü Imágen A y B: Neovasos que exudan lípidos.


ü Es una infección de la cornea de evolución crónica.
ü Se caracteriza por un infiltrado estromal blanco arboriforme o en forma de helecho, asociada a una mínima reacción inflamatoria (Imagen A y B).
ü Es una infección de lenta evolución, con poca respuesta al tratamiento antimicrobiano, por lo que suele requerir tratamiento quirúrgico .
ü La mayoría de estas infecciones ocurren en córneas trasplantadas que están en tratamiento con corticoides tópicos, aunque también pueden tener lugar en córneas normales, sin ninguna patología ni antecedente.
ü Estas queratopatías han sido asociadas con maniobras postquirúrgicas de la sutura; con defectos epiteliales persistentes; con el uso crónico de esteroides tópicos, subtenoinianos e intravítreos, con uso de lentes de contacto y abuso de anestésicos tópicos.
ü Los microorganismos que se aíslan con mayor frecuencia corresponden al grupo de Streptoccoccus viridans, Pseudomonas spp, Haemophilus spp y Cándida spp.
Galperin G., Boscaro G., Tau J., Berra M. Queratopatía cristalina: diagnóstico clínico y microbiológico de una infección corneal infrecuente causada por el grupo Streptococcus mitis. Revista argentina de microbiología 43(3): 195-197. Septiembre 2011 Cárdenas Díaz Taimí, Guerra Almaguer Michel, Hernández López Iván, Cruz Izquierdo Dunia, Miranda Hernández Iramis. Queratopatía cristalina en EL-DSEK. Rev Cubana Oftalmol [Internet]. 2015 Mar [citado 2023 Abr 24] ; 28( 1 )


ü Pseudomona aeruginosa, es el patógeno gram negativo más frecuentemente aislado en queratitis grave.
ü Su prevalencia está correlacionada con uso de lente de contacto blandas.
ü La presentación clínica se caracteriza por inicio rápido de dolor que se acompaña por inyección conjuntival, fotofobia y descenso de la visión (clínica común en pacientes con úlceras corneales bacterianas).
ü La P. areuginosa produce necrosis del estroma con una superficie frondosa de exudado mucopurulento adyacente.
ü Es frecuente la presencia de una placa inflamatoria endotelial y reacción importante en cámara anterior e hipopion.
Preferred Practice Patterns Committe, Cornea/External Disease Panel. Bacterial Keratitis. San Francisco: American Academy of ophthalmology; 2008.


ü Defecto epitelial con infiltrado estromal asociado a exudado mucopurulento adyacente.
ü Brillo corneal alterado.
ü Pliegues de la descemet
ü Fibrina en cámara anterior
ü Hipopion.
ü Hiperemia e inyeccion conjuntival.
ü Vasos telangectasicos en borde palpebral
ü Secreción mucupurulenta en fondo de saco
ü Tinción de Úlcera con fluoresceína
Caso aportado por Dra. María José Vergara



ü Paciente con antecedentes de mal uso de lente de contacto evoluciona con dolor intenso en ojo derecho por lo que consulta en el policlínico de choque del Hospital del Salvador.
ü Defecto epitelial
ü Hipopion
ü Hiperemia e inyeccion conjuntival
ü Tinción de Úlcera con fluoresceína
ü Pannus
ü Brillo corneal alterado.
ü Pannus
ü Adelgazamento corneal


ü La úlcera micótica es menos frecuente que la bacteriana, representando menos del 5-10 % de infecciones en las series clínicas descritas en EE. UU.
ü La queratitis micrótica filamentosa es más frecuente en las zonas más cálidas y húmedas.
ü Dentro de los factores de riesgo: traumatismo vegetal (el más importante), lente de contacto, corticoesteroides tópicos, cirugía corneal y la queratitis crónica.
ü Suelen tener menos signos y síntomas inflamatorios durante el período inicial que cuando tienen queratitis bacteriana.
ü La queratitis micótica filamentosa se manifiesta como:
- Infiltrado blanco-grisáceo de aspecto seco y bordes a modo de plumas o filamentos irregulares.
- Las lesiones superficiales pueden tener aspecto blanco grisáceo, elevar la superficie corneal y tener una textura secca, áspera o arenosa en el momento del raspado corneal diagnóstico.
- En ocasiones, puede haber infiltrados multifocales o satélites, aunque son menos frecuentes de lo que se creía con anterioridad.
- Puede haber un infiltrado profundo en el estroma en presencia de un epitelio intacto, así como una placa endotelial o hipopión si los infiltrados micróticos son suficientemente profundos o grandes.
ü A medida que progresa la queratitis pueden desarrollar una supuración intensa.
ü Las úlceras micóticas pueden evolucionar con perforación.
Caso aportado por Dr. Nathan Dukes
ü Hombre 70 años hace 2 semanas “le cae jugo de uva en ojo izquierdo” Desde entonces con disminución progresiva de la AV asociado a dolor y ojo rojo. Por lo anterior es evaluada en el Hospital del Salvador diagnosticándole “úlcera corneal grave del ojo izquierdo” por lo que se le solicita cultivo que resulta positivo para hongo filamentoso.
ü Por lo anterior se inicia tratamiento tópico con voriconazol sin embargo paciente requiere recubrimiento conjuntival en dos oportunidades.
ü El día 40 de tratamiento se logra iniciar tratamiento con natamicina.
ü Ambas imágenes corresponden al día 40 desde el inicio de la enfermedad.

ü Residuos de recubrimiento conjuntival.
ü Infiltrado blanco-grisáceo con supuración intensa.
ü infiltrados multifocales o satélites

Caso aportado por Dr. Cristian Sanchez
ü Hombre 34 años cuya ocupación consiste cargar frutas y verduras refiere que hace 1 mes comienza con dolor de ojo derecho asociado a ojo rojo. Consulta en el Hospital de arica en donde se observa espina en la corna asociada a una ulcera corneal. Se sospecha úlcera corneal de etiologia micótica por lo que se solicita cultivo que resulta positivo para Fusarium Spp.

ü Inyección conjuntival
ü Úlcera corneal de 3mm de diámetro, bordes plumosos
ü Hipopion de 2mm
ü Recubrimiento conjuntival


ü Coalescencia de infiltrados formando un absceso corneal
ü Adelgazamiento corneal
ü Adelgazamiento corneal
ü Melting corneal

Imagen A y B
ü Úlcera corneal por streptoccocus pneumoniae la cuál evolucionó con neovasculatizacion y crecimiento gradual de infiltrados cuya coalescencia formó un absceso.
ü La membrana de descemet protruyó dado que las capas de la cornea evolucionaron con un melting .
ü En este caso la evolución desfavorable fue producto de falta de cooperación del paciente por diversos motivos para seguir el tratamiento.
Caso aportado por Dr. Yuri Mercado


ü Atalamia
ü Coalescencia de infiltrados formando un absceso corneal
ü Melting corneal
ü Ojo rojo periquerático



ü Aniridia es un trastorno panocular bilateral.


ü La causa de aniridia es un defecto en el gen PAX 6 situado en la banda 11p13, que puede ser autosómica dominante 2/3 de los casos o esporádico en 1/3 de los casos.
ü La aniridia esporádica, como es el caso de este paciente, se asocia a el tumor de Wilms en un tercio de los casos.
ü La cantidad de iris presente varía desde una ausencia casi total hasta solo una leve hipoplasia.
ü El glaucoma, la hipoplasia del nervio óptico, hipoplasia de la fovea y las cataratas son comunes. La opacificación corneal aparece más tarde en la infancia. La cornea parece desarrollar un pannus que afecta gradualmente la visión central.
ü La presentación típica es la de un lactante con nistagmo que parece no tener iris o que tiene pupilas dilatadas que no son reactivas. Puede haber además fotofobia. En la exploración hay con frecuencia cataratas polares anteriores pequeñas con fibras de membrana pupilar persistente unidas.


BAü La catarata lamelar también denominada zonular, es la más frecuente de las cataratas infantiles.
ü Se puede heredar en forma autosómica dominante.
ü Se presentan como opacidades bilaterales del núcleo y son el resultado de un daño al cristalino durante el desarrollo fetal siendo las capas más internas afectadas en mayor importancia mientras más precoz haya sido el daño.
ü Clínicamente se caracteriza por la presencia de opacidades en el cristalino que semejan protuberancias en forma de dedos proyectánddose a partir de un núcleo opacificado asociada con regiones de opacidad pulverulenta (Imagen A y B).
Messina O, González L, Cuevas S. Espectro clínico en una familia con catarata lamelar autosómica dominante. Rev Mex Oftalmol; Mayo-Junio 2005; 79(3): 163-165.


Imágenes A, B, C y D
ü Imágenes se observa atrofia esencial del iris asociado a catarata intumescente y zonulodialisis.
ü Se observa adelgazamiento parcial del iris que al progresar se convierte en agujeros, desplazando la pupila en direccion contraria a la atrofia. A

ü La atrofia esencial del iris es una condición infrecuente que se presentra mas en mujeres y de forma unilateral. Hay que descartar causas secundarias.


ü La uveitis anterior se define como una Inflamación en camara anterior e incluye iritis, iridociclitis e hialitis.
ü Incidencia es de 8-21/100.000.
ü Prevalencia 68/100.000.
ü H=M, todas las edades, más en los extremos de vida.
ü 50% son idiopáticas.
ü Clínica:
-Edema palpebral
-Ojo rojo profundo
-Opacidad corneal: Por HTO, endotelitis
-Queratopatía en banda
-Tyndall celular
-Tyndall albuminoso o flare
-Precipitados queráticos (PK)
-Sinequias anteriores, posteriores
-Iris bombé
-Miosis
-Atrofia iris
-Neovascularización ángulo
-Dilatación de vasos iridianos
ü Complicaciones: Sinequias posteriores, Glaucoma, Catarata y Edema macular.

ü La uveítis asociada al virus del herpes simple (VHS) es una causa frecuente de uveítis anterior hipertensiva unilateral.
ü La uveítis anterior herpética causa aproximadamente del 5 al 10 % de los casos de uveítis
ü La uveítis anterior asociada al HSV es más común en pacientes de 40 a 50 años y afecta a ambos sexos por igual.

ü La historia o signos clínicos de enfermedad ocular previa por VHS también nos orientan al diagnóstico.
Clínica:
ü Gerenalmente se presenta como una queratouveitis aunque la uveitis puede ocurrir sola, sin evidencia de queratitis.
ü Unilateral.
ü Presión intraocular elevada provocada por la traveculitis.
ü Defectos parchados de transiluminacion en el iris, aunque su ausencia no la descarta. La atrofia del iris, que con frecuencia está localizada, tiende a producir distorsión pupilar.
ü Precipitados queraticos finos o granulomatosos central o inferior (triangulo de arlt).
ü Pueden presentar hifema asociado.
ü Hipoestesia cornea.

ü Imagen A: Atrofia iridiana sectorial asociada a una pupila semimidriasis
ü Imagen B: Precipitados queraticos finos inferior

Ophtalmol. 1996; 114 (9): 1065-1072.
ü
Hombre 53 años con anteccedentes de facoemulsificación + implante de lente OD, consulta tras episodios de uveitis hipertensiva a repetición asociados a hifema del ojo derecho.


ü AV 0.7 OD
ü PIO OD: 28mmHg
ü BMC (Imagen A y B): Córna transparente, cámara anterior formada, Tyndall +, LIO in situ, transiluminación sectoriales del iris, iridotomías superior e inferior. Nevus conjuntival.
Caso
ü Gonioscopía (Imagen C): Ángulo abierto en en 270º, trabéculo con pigmento, SAP inferior

ü Fondo de ojo (Imagen D): Papila pálida con excavación 0.9. macula sana

ü El Sd. UGH es una complicación que puede aparecer en el post operatorio (precoz o tardío) luego de la implantación de un lente intraocular.
ü Se define clásicamente por la triada que su nombre comprende, aunque pueden aparecer formas incompletas.
ü La incidenccia se ha visto aumentada debido al incremento de la cirugía de cristalino, ya sea por catarata o con finalidad refractiva.
ü La patogenia se debe a la presión ejercida por los hápticos del lente intraocular (LIO) sobre el tejido uveal y puede presentarse en paciente con lentes en cámara anterior, sulcus o saco.
ü Sospechar en paciente pseudofáquico con episodios recurrentes de uveitis no filiada C D
Imágenes


ü Estrías de la Haab (rotura de la descemet)
ü Catarata nuclear

Las estrías de Haab corresponden a roturas cicatrizadas de la membrana de Descemet que aparecen como líneas horizontales o concéntricas, aisladas o múliples distribuidas de forma paralela. Las estríás de Haab se ven mejor a través de la transilminación tras la dilatación de la pupila.
Glaucoma congénito primario. Oftalmología pediátrica y estrabismo ( Pag 486). El servier .

ü Pupila en semimidriasis
ü Opacidades lechosas debajo de la cápsula del cristalino.
ü Pigmento a nivel del endotelio

ü El glaukomflecken corresponde a opacidades lechosas debajo de la cápsula ddel cristalino que se producen después del glaucoma de ángulo cerrado agudo, debido al bloqueo pupilar.
ü El glaukomflecken por ende se produce por isquemia e histopatológicamente está compuesto por células epiteliales de lentes necróticas y corteza subepitelial degenerada.
Caso aportado por Dr. Nathan Dukes
ü Hombre 39 años con antecedentes de Axenfeld Rieger y glaucoma asociado acude a control en Hospital del Salvador.

ü Hipoplasia estromal del iris - Policoria
ü Embriotoxon posterior
ü Tubo de Válvula de ahmed
ü Ectopia pupilar
ü Adherencia irido corneales
ü El síndrome de Axenfeld-Rieger (SAR) es una entidad rara, autosómica dominante, que se caracteriza por una penetrancia completa y expresividad variable.
ü Los defectos oculares clásicos del síndrome de Axenfeld-Rieger incluyen hipoplasia del iris, adherencias iridocorneales, corectopia, policoria, embriotoxon posterior, y otros rasgos menos frecuentes como cataratas, desprendimiento de retina y microcórnea.
ü Aproximadamente la mitad de los individuos afectados desarrollan glaucoma.
ü Las anomalías sistémicas asociadas incluyen las malformaciones faciales (telecantus, hipoplasia del maxilar), anomalías dentarias y piel periumbilical redundante entre otras.
Shields MB, Buckley E, Klintworth GK & Thresher R. Axenfeld-Rieger syndrome. A spectrum of developmental disorders. Surv Ophthalmol. Mayo-Junio, 1985; 29(6):387-409

Bü Burbujas de silicona en cámara anterior
ü Opacidad corneal + neovascularización
ü
Esfinter pupilar roto ü Catarata
ü Iridotomía

Complicaciones secundarias al uso de silicona en el segmento anterior : ü La uolización de silicona favorece el desarrollo de cataratas.
ü La migración de silicona hacia cámara anterior puede, por contacto directo con el endotelio corneal, dar lugar a descompensaciones corneales y queratopapa en banda (26% en 2 años).
Imágenes aportadas por Dr. Nathan Dukes


ü Imagen A, B y C muestran Subluxación del lente intraocular en paciente con pseudoexfoliación. Sin antecedentes de trauma previo.
ü El síndrome de pseudoexfoliación es un desorden de la matriz extracelular, relacionado con la edad, caracterizado por la producción y depósito de un material brilar en varios tejidos intraoculares y extraoculares.
ü Puede ser unilateral o bilateral y es un factor de riesgo mayor para desarrollar glaucoma secundario de ángulo abierto.
ü Consotuye la causa idenocable más común de glaucoma en el mundo y la causa más frecuente de glaucoma unilateral.

A. Coriorrehnihs por Toxoplasma
B. Coriorrehnits por Toxoplasma
C. Granuloma de polo posterior por Toxocariasis
D. Neurorrehnihs por Bartonella Henselae
E. Necrosis rehnal aguda
F. Necrosis rehnal aguda bilateral por Citomegalovitus (CMV)
2. PATOLOGÍA VASCULAR RETINIANA
A. Coroidopaia hipertensiva
B. Rehnopaia hipertensiva exudahva
C. Tumor de cuerpo caroideo + oclusión de rama arterial con isquemia macular
D. Oclusión de rama arterial temporal superior
E. Trombosis de vena central de la rehna
F. Trombosis venosa de rama
G. Membrana neovascular coroidea en paciente con degeneración macular relacionado a la edad (DMRE)
3. PATOLOGÍA TUMORAL
A. Melanoma coroideo
B. Melanoma amelanóhco
4. PATOLOGÍA HEMATOLÓGICA
A. Rehnopaia por leucemia mieloide aguda
B. Infiltración de nervios óphcos por leucemia
C. Rehnopaia por leucemia linfáhca aguda PHI +
5. PATOLOGÍA GENÉTICA
A. Coloboma de papila y coriorrehnal
B. Coroideremia (ligada al X)
C. Albinismo ocular
6. MIELINIZACIÓN DE FIBRAS NERVIOSAS RETINALES
7. FOSETA ÓPTICA
8. COATS
9. HIPERTROFIA CONGÉNITA DEL EPITELIO PIGMENTARIO
10. EDEMA DE PAPILA
11. DESPRENDIMIENTO DE RETINA + DESGARRO RETROLENTAL



BAü 2º Causa de uveios después del VKH (sólo se conoce la eoología de uveios en un 40%)
ü Seroprevalencia en Chile 24.6-36.9%, más frecuente hacia el sur y areas rurales
ü Huesped definiovo es el gato
ü Se transmite por ingesoon de carne cruda o no cocida; ingesta de agua, vegetales, frutas contaminadas; transplacentaria; transfusión sanguínea e inoculación directa por penetración de la piel con jeringas
ü 90% asintomáocos al infectarse
CLÍNICA:
Coriorreonios focal
ü Lesión solevantada color blanco amarillentos o blanco grisaceos adyacente al extremo de una cicatriz pigmentada inacova anogua
ü “Faro en la niebla” (cuesta ver nervio ópoco por la vitreios)
ü Se asocia a vitreios
Corioidios de jensen:
ü Papilios
ü Lesión granulomatosa papilar
ü Cicatriz pigmentada inactiva antigua

ü Lesión solevantada de color blanco amarillento

ü Cicatriz pigmentada inactiva antigua
Imagen A: ü Lesión solevantada, de color blanco amarillentos .



ü Granuloma periférico al nervio óptico con banda vítrea papilofílica (imagen A, B y C). A
B C

ü Toxocariasis es una zoonosis causada por un helminto, huesped habitual del intestino del perro y el gato. Tras la infestación a humano por vía digestiva a través de ingesta de alimentos o tierra contaminada con huevos y la migracion de la larvas, aparece la infección
ü Factor de riesgo: tener perros, geofagia
ü Edad promedio de presentación 7 años
ü Clínica: Granuloma que puede ser periférico de nervio óptico o de polo posterior con banda vítrea papilofílica


ü Bartonella henselae es el causante de la enfermedad por arañazo de gato
ü Corresponde a el agente que con mayor frecuencia produce neurorretinitis
ü Sospechar cuadro en niños
ü Consultar por contacto con gato
Clínica:
ü Neurorretinitis
ü Vasculitis, Obstrucción vascular. ü Cuadro de presentación más frecuente:
-Disminución agudeza visual
-Estrella macular
-Papila bordes borrosos
-Exudación lipídica

ü La NRA fue descrito como un síndrome de panuveítis aguda con periarteritis retinal que progresa a retinitis necrosante difusa y desprendimiento de retina.
ü Es causado por virusd herpes humano y puede afecta a inmunocompetentes o inmunosuprimidos de ambos sexos a cualquier esad.
ü Incidencia: 0.5-0.63 casos por millón de habitantes.
ü Clínica:
• 1 o más focos de necrosis retineana con bordes discretos localizados en la retina periférica
• Progresión rápida en ausencia de terapia antiviral
• Diseminación circunferencial
• Evidencia de vasculopatía oclusiva con afectación arterial
• Reacción inflamatoria prominente en el vítreo y cámara anterior
ü Diagnóstico diferencial de la necrosis retinal aguda: endoftalmitis bacteriana endógena, endoftalmitis fúngica, enfermedad de Behcet, linfoma intraocular, necrosis retinal externa citomegalovirus, sarcoidosis, toxoplasmosis ocular.


Caso clínico
Hombre 45 años, sin antecedentes móbidos, consulta por cuadro de 11 días de evolución caracterizado por dolor en OD, ojo rojo asociado a disminución de la AV.



Ojo derecho
AV: 20/70 con agujero estenopéico.
PIO: Elevada
Biomicroscopia:
ü Precipitados querálcos endoteliales ü Tyndall +2 ü Nódulos de Koeppe ü Midriasis
ü Cristalino transparente ü Vítreo con células y pigmento.


Ojo derecho
Fondo de ojo: focos retinales en periferia inferior y temporal de necrosis retinal y vasculitis arteriolar
A la angiografía con fluoresceína (Fase activa)
ü Las áreas perfundidas demuestran una hiperfluorescencia en tiempos venosos con fuga tardía tanto a nivel tisular como vascular.
ü Las áreas isquémicas presentan una hipofluorescencia precoz con hiperfluorescencia por impregnación escleral tardía.
Clement F “Angiografía” Diagnóstico por la imagen en la retina, Sociedad Española de Retina y Vítreo, editado por Ignasi Jügens, Elservier, 2014, pp 41-66 A


 Fase A-V (arterio-venosa)
Fase venosa
Fase A-V (arterio-venosa)
Fase venosa
ü La necrosis retinal aguda es una panuveítis, que en el caso descrito a continuación se dio en un pacientede 4 años inmunosuprimido
ü CMV es una causa inhabitual de NRA
ü Puede ser unilateral o bilateral asincrónica Clínica
ü Áreas de necrosis retinales focales, bien delimitadas en la periferia, más allá de la arcada vascular temporal
ü Rápida progresión de la necrosis, circunferencial, cuando no se instaura tratamiento antiviral
ü Evidencia de vasculopatía oclusiva con compromiso arteriolar
ü Reacción inflamatoria vítrea y de la cámara anterior.
ü Otras características menos frecuentes incluyen la neuropatía óptica y escleritis.
Caso clínico
ü Niño de 4 años, con antecedentes de púrpura trombocitopénica amegacariocítica, recibe transplante de progenitores hematopoyéticos. Sin embargo, paciente evoluciona con infección sistémica por CMV por lo que se decide iniciar tratamiento con Foscartet EV (actualemente está en su 7º día de tratamiento).
ü Por lo anterior se solicita evaluación por oftalmología para descartar compromiso ocular.

Examen Físico
AV: no coopera
PIO no registrado
Fondo de ojos:

ü OD: Lesión blanquecina a temporal de la mácula, vecina a fóvea (Imagen A)
ü OI: Lesiones blanquecinas granulares y hemorrágicas en arcada temporal superior (Imagen B)


A B C

ü La hipertensión arterial (HTA) mal controlada produce un daño de la microcirculación retinal
ü La HTA es el mayor factor de riesgo para otras enfermedades retinales como son las oclusiones retinales arteriales, venosas y la neuropatía óptica isquémica entre otras.
ü La coroidopatía hipertensiva se suele presentar en pacientes jóvenes con una HTA aguda, y esta asociada casi siempre a compromiso multisistemico. Esta puede o no estar asociada a retinopatía hipertensiva
ü La coroidopatía hipertensiva se caracteriza por presentar alteraciones del lecho vascular coroideo (manchas de elsching y manchas de siegrist ambas corresponden a signos de oclusión vascular coroidea previa), lesiones del epitelio pigmentario y desprendimiento de retina
-La mancha de elsching son redondeadas con un centro pigmentado y un halo atrófico blanco amarillento y corresponden a infartos coroideos isquémicos
-Las manchas de siegrist se presentsa como una línea de cúmulo de pigmentos
Rodríguez N, Zurutuza A. Manifestaciones oftalmológicas de la hipertensión arterial. Anales Sis San Navarra vol.31 supl.3 Pamplona 2008 Control a los 10 días



ü La retinopatía hipertensiva (RH) es considerada un indicador de daño sistémico, su presencia predice accidente cardiovascular, insuficiencia cardíaca y mortalidad cardiovascular ü La Fase exudativa se produce cuando se sobrepasan los mecanismos de autorregulación de los vasos retinales y se rompe la barrera hemorretinal interna y por ende los vasos dejan que salga su contenido apareciendo de esta manera las hemorragias, exudados lipídicos, manchas algodonosas (microinfartos retinales) y edema.
ü La mayor cantidad de elementos que veamos en el fondo de ojo dependen de la cronicidad del cuadro y la edad del paciente.
ü Hemorragia
Retinales
Imágenes
ü Hemorragia
Subretinal

ü Hemorragia
Preretinal

ü Hemorragia peripapilar

ü

ü Hemorragia
ü
Subretinal
ü Los tumores del cuerpo carotídeo son lesiones raras también llamados paragangliomas por su origen de tejido paragangliónico extraadrenal
ü Son frecuentemente observados en pacientes que habitan regiones de elevada altitud
ü Pueden ser esporádicos o familiares y se asocian a paragangliomas en otros sitios
ü Se presentan como masa palpable asintomática a nivel del ángulo de la mandíbula
ü El diagnóstico se realiza con angiografía carotídea; sin embargo, avances recientes han hecho posible el diagnóstico basado en tomografía, resonancia, angiorresonancia magnética y ecografía Doppler color
ü La mayoría son tumores benignos, aunque existe la posibilidad de malignidad, la cual está determinada por invasión a órganos contiguos, presencia de metástasis ganglionares o a distancia y recurrencias
Caso clínico
ü Paciente mujer de 32 años con aumento de volumen cervical derecho desde el 2010
ü En la angiografía carotídea de Enero 2019 se evidencia un tumor de glomus carotíodeo derecho con oclusión total de la arteria carótida interna derecha. Arteria vertebral derecha de gran tamaño, permeable
ü Por lo anterior le realizan un procedimiento de embolización de tumor carotídeo
ü Paciente evoluciona desfavorablemente con un escotoma central OD a las 20 horas posterior al procedimiento


Caso aportado por Dr. Cristian Sánchez
Clínica:
AV: OD CAE =0,2 / OI 0,8
PIO: OD 10/ OI: 16
BMC: Polo anterior normal
FO: Oclusión de la arteria ciliorretinal con isquemia macular OD
Obstrucción de la arteria ciliorretinal (OACR)
ü La arteria ciliorretiniana esta presente en 15-30% de los ojos
ü Es rama de arterias ciliares cortas posteriores
ü La etiología de la OACR suele estar relacionada con enfermedad carotídea u otros procesos tromboembólicos relacionados con estados de hipercoagulabilidad y autoinmunidad.
ü El diagnóstico suele ser fundoscópico con la visualización en nuestro caso del área retineana isquémica en el terrirotio de la arteria ciliorretineana y la visualización del embolo.
Peral,






D
RETINAL CON ISQUEMIA MACULAR OD
Caso aportado por Dr. Cristian Sánchez

ü


En las obstrucciones arteriales retineanas en la angiografía con fluoresceína en fase aguda existe un retraso marcado en el relleno de la arteria central de la retina o de sus ramas, con hipofluorescencia a lo largo de todo el angiograma de los territorios isquémicos por falta de relleno y efecto pantalla por el edema neurorretiniano (Imagen E y F). ü Campo visual computarizado 30-2: Mide los 30º temporales y nasales. En este caso el defecto en el campo visual es concordante con la clínica de la paciente (Imagen G y H).


Imagen A y B
ü Embolo situado en la bifurcación de la arteria temporal superior ü
Opacificación retinal a nivel de la arcada temporal superior
Oclusión de rama de la arteria central de la retina:
ü Pérdida brusca de parte del campo visual
ü Ramas superotemporales más frecuentes
ü Opacificación retinal sectorial
ü Disminución calibre arterial sectorial
ü Fragmentación circulación retinal sectorial
ü Presencia de émbolo 68%
ü Pronóstico visual generalmente bueno
ü Defecto residual en el campo visual


Trombosis de la vena central de la retina
ü Se presenta habitualmente en pacientes mayores con enfermedad cardiovascular
ü Dentro de los factores de riesgo tenemos la edad >50ª, HTA, Dislipidemia y DM ü Suele ser de presentación unilateral Fondo de ojo (Imágenes A y B): Las siguientes alteraciones se ubican en los 4 cuadrantes)
ü Dilatación y tortuosidad de venas
ü Hemorragias superficiales en llama o intrarretinal y a veces hemorragias vitreas
ü Puede presentar (no presente en las imágenes): Edema de papila, Manchas
Retinografia anerita (libre de rojos)
ü
Hombre 60 años con antecedentes de hipertensión arterial refiere cuadro de 10 días de evolución de disminución de la agudeza visual indolora.
ü Hemorragia en 4 cuadrantes
ü Tortuosidad de las venas
ü OCT evidencia edema macular cistoide

Aü Hemorragias superficiales e intrarretinales en 4 cuadrantes
ü Dilatación venosa y aumento de su tortuosidad
Clement

A
ü Mujer 65 años con antecedentes de HTA, refiere cuadro de 1 mes de evolución caracterizado por disminución monocular de la agudeza visual del ojo izquierdo.

ü Hemorragia retinal que compromete de manera predominante hemirretina inferior
Bü Epidemiología: igual a la TVCR descrita anteriormente
ü Fondo de ojo: En el cuadrante comprometido paciente puede presentar dilatación y tortuosidad de venas, hemorragias en llamas o intrarretinal y a veces hemorragias vitreas. También pueden presentar (no es el caso de la imagen) edema de papila, manchas algodonosas y edema macular.
ü Retinografia de campo amplio (Imagen A y B): gran Hemorragia intrarretinal que compromete arcada temporal inferior asociado a hemorragias puntiformes en polo posterior.


ü La degeneración macular relacionada a la edad es la causa más frecuente de pérdida de visión irreversible en personas mayores de 60 años
ü La patogenia es multifactorial, en que además del envejecimiento (principal factor de riesgo) los factores de riesgo genéticos y ambientales (Tabaquismo, obesidad abdominal) juegan un rol determinante
ü Su primera manifestación son las drusas sin embargo el proceso puede evolucionar a la forma seca o húmeda
ü La forma húmeda se caracteriza por la presencia de membrana neovascular coroidea que crece bajo el epitelio pigmentario y luego bajo la retina. Estos vasos de neoformación se originan en la coriocapilar, proliferan y penetran al espacio subepitelial a través de una ruptura de la membrana de Bruch
ü El desprendimiento de epitelio pigmentario puede preceder la neovascularización coroidea, y en ese caso su contenido es seroso, cuando se asocia a neovascularización coroidea su contenido es fibrovascular
ü Al examen oftalmoscópico, en caso de tener una membrana neovascular, se detecta un solevantamiento retinal, habitualmente redondeado y generalmente rodeado de un halo de sangre subretinal. El solevantamiento se debe a la presencia de líquido o edema retinal. La membrana neovascular puede ser extrafoveal, alejada del centro, pero en la mayoría de los casos es subfoveal
ü Una complicación inusual es la hemorragia subretinal masiva, lo que en algunos pacientes se asocia a terapia anticoagulante
ü Angiografía con fluoresceína en la membrana MNVC Tipo Ia (DEP fibrovascular): se caracteriza por presentar área hiperfluorescente irregular visible desde un tiempo arteriovenoso precoz que incrementa la fluoresceina en tiempos tardíos con poca o nula difusión

Aü Fondo de ojo OD (Imagen A, B y C): Lesión pigmentada localizada a nasal a nivel coroideo, cuyas mediciones son de aprox 10x4mm en sus ejes cefalocaudaltransversal respectivamente
ü Mujer 70 años refiere cuadro de 1 mes de evolución caracterizado por fotopsias y entopsias en ojo derecho con AV conservada.


Imagen D y E
ü Desprendimiento de vitreo posterior
ü Desprendimiento de retina focal inferior exudativa
ü Se constata lesion nasal 3hrs, forma de cupula cuyos diámetros máximos son:
-Al corte longitudinal: Base: 10.85nm, altura 2.58nm
-Al corte transversal: Base 8.81nm; altura 3.64nm con elementos de vascularidad


Dü El melanoma coroideo es el tumor primario intraocular más frecuente en el adulto
ü La mayoría puede diagnosticarse por sus signos clínicos, sin embargo existe un porcentaje de melanomas que requieren ecografías para diferenciarlos de otras lesiones pigmentadas
ü Para conseguir diferenciar con seguridad que estamos frente a un melanoma, el tumor debe superar los 2-2.5mm de grosor
ü Su morfología puede variar, siendo cupuliforme (la forma más frecuente) o presentando creciemiento <<en champiñon>> (forma carácterística, especialmente en tumores de gran tamaño, debido a la ruptura de membrana de Bruch). Menos frecuentemente puede ser binodular, multinodular o difuso
ü Es un tumor de celularidad densa, lo que se traduce en una ecogenicidad media– baja, estructura interna homogénea y gran atenuación. Es por ello que se aprecia el denominado ángulo kappa en el modo A, en el que aparece un primer piso alto correspondiente a la retina con una disminución marcada de los ecos posteriores y sombra posterior en eco B.
ü Característicamente presenta un alto flujo vascular en la base, por lo que aparecen <<flickering spikes>>. También es típica la excavación coroidea expresada como una baja ecogenicidad en la base del tumor
ü La ecografía es una técnica que también nos permite valorar, con una gran sensibilidad, la extensión extraescleral de un melanoma uveal. Para que esta pueda ser detectada debe ser igual o superior a 1.5mm, apreciándose un área vacío ecogénico bien delimitado, homogéneo, adyacente a la masa intraocular
ü La ecografía también nos permite valorar la presencia de un desprendimiento de retina seroso que habitualmente se extiende desde el margen tumoral hacia la zona ocular inferior


ü Imagen C: Lesión sólida ligeramente irregular, homogénea, de reflectividad media baja con elementos de vascularidad en su interfase. Altamente consistente con melanoma de coroides
ü Mujer 57 años consultó en policlínico por cuadro de disminución de la agudeza visual de hemicampo superior del ojo derecho, indoloro de 1 mes de evolución
ü Imagen B: Subyacente al DR hay una lesion sólida dependiente de la coroides, irregular en base (18.8mm) y altura (1.63)

ID:
DOB:
Gender:
OSORIO CARPIO, GLORIA
Female 10/11/1962 8022643-8
Exam Date:
Exam Time:
Serial Number: 5000-2474
Technician:
Name: 2/10 9:21 2/26/2020
Tecnologos, HDS
Signal Strength:
High Definition Images: HD 5 Line Raster
HOSPITAL DEL SALVADOR

Length:
Spacing: Scan Angle: 9 mm 0.25 mm 9°
ü Imagen D y E: Lesión coroidea que levanta la macula, asociada a líquido subretinal
Comments
Imagen A y B:
ü Hemorragias en llamas
ü Focos blancos algodonosos
ü Manchas de Roth

ü Las manifestaciones típicas de la leucemia reflejan el cuadro general de anemia o pancitopenia, con hemorragias intrarretinianas e infartos de la capa de fibraas nerviosas (manchas algodonosas). Dentro de las hemorragias tenemos las ”manchas de Roth” que corresponden a hemorragias intrarretineanas con centro blanco
ü En ocasiones puede encontrarse infiltración leucémica de la retina, de la papila óptica o de la coroides, normalmente en la región peripapilar

ü Puede haber compromiso neuroftalmológico como edema de papila por hipertensión intracraneana cuya diferencia con la infiltración directa esta dada por la toma de AV o DPAR
ü En estos paciente siempre se debe descartar compromiso secundario por infecciones oportunistas
ü Hombre 19 años portador de Leucemia linfatica aguda diagnosticada el 2016, es tratado ese mismo año con trasplante alogénico, sin embargo 4 meses posterior al trasplante sufre una recaída leucémica. Desde entonces el paciente se ha mantenido en QMT sistémica paliativa
ü El año 2017 el paciente evoluciona con enfermedad injerto contra huesped y el 2018 con meningitis leucémica
ü El año 2019 consulta en el policlínico de oftalmología del Hospital del Salvador por disminución de AV ODI de 7 dias evolución, asociado a sensación de cuerpo extraño.

Examen Físico
ü AV con CAE: 20/70 OD y 20/60 OI
ü PIO normal bilateral
ü DPAR en OD
ü Motilidad ocular conservada.
ü BMC: Puntata extensa como consecuencia de efectos adversos producidos por la QMT (Imagen A y B) A
ü Los efectos secundarios oculares de la QMT anticancerosa son relativamente poco comunes, sin embargo debido al gran aumento del uso de anticancerosos se han visto con mayor frecuencia

Bü Los anticancerosos pueden afectar a cualquier segmento del globo ocular, en el caso de este paciente se vió afectado el segmento anterior. Las alteraciones más frecuentes que se presentan en el segmento anterior son a nivel de la película lagrimal, lo que conduce a daños en el epitelio corneal y conjuntiva.
ü La anticipación de diversas toxicidades oculares producto de los medicamentos puede proporcionar una oportunidad para desarrollar estrategias para minimizar o eliminar efectos esperados
ü Se recomienda al médico examinar a los pacientes al inicio y después cada tres meses según hallazgos

Exámenes
ü Destaca anemia severa, leucocitosis de 10850 cel/ml con predominio linfocitario de 82%
ü Tomografía computada de cerebro contrarrestada sin lesiones parenquimatosas
Diagnóstico
FDO (Imagen C y D): Edema de papila bilateral, hemorragia retinales en llama peripapilares y lesiones blanquecinas que corresponden a “manchas algodonosas" peripapilares bilaterales.
Aumento de la tortuosidad vascular y hemorragias puntiformes en polo posterior

ü Se diagnostica infiltración leucemica de ambos NO Manejo
ü Debido a manejo conservador de leucemia se decide manejo expectante
ü Las leucemias son un grupo de neoplasias malignas hematológicas que derivan de leucocitos inmaduros. Aparte de sus síntomas clásicos las manifestaciones oftalmológicas se presentan hasta en el 90%. Estas últimas pueden ser manifestaciones directas (infiltracion uveal del segmento anterior, infiltración orbitaria, infiltración del nervio óprico (NO), paresias de nervios craneales y papiledema) o indirectas. La presencia de compromiso ocular está asociado con peor pronóstico y puede ser el único signo de recaída
ü El examen oftalmológico en los pacientes con leucemia es fundamental, ya que el compromiso ocular está asociado a peor pronóstico vital. El compromiso del NO puede ser extensión leucémica directa del compromiso del sistema nervioso central, o edema por invasión retrolaminar. El ojo está fuera del alcance de la quimioterapia intratecal, se podría intentar con radioterapia local y quimioterapia sistémica. En el presente caso se decidió solo observación dado mal pronóstico vital.
OMOTI, Afekhide Ernest y OMOTI, Caroline Edijana. Toxicidad ocular de la quimioterapia sistémica anticancerosa. Pharmacy Pract (Granada) [online] 2006, vol 4, n 2 [citado 2021-06-15], pp 55-59 Disponible en: <http://scielo.isciii.es/scielo.php?script=sci_arttext&pid=S1885-642X2006000200001&lng=es&nrm=iso>.
ü
Caso aportado por Dr. Nathan Dukes
Hombre 61 años con antecedentes de pérdida de la AV súbita del ojo izquierdo hace 3 meses, consulta por cuadro de 3 días de evolución caracterizado por aumento de volumen palpebral asociado a dolor del ojo izquierdo.


Imagen A
ü
Edema palpebral
ü Ptosis
ü Exoftalmo
ü
Exotropia A


Imagen D
ü Infiltración extraconal y de los rectos
ü edema palpebral

ü Paciente de 21 años derivado al policlínico de genética por Sd. De CHARGE.

ü El síndrome de CHARGE se debe a una mutación en el gen CHD7
ü La incidencia estimada es de 1/10.000 nacidos vivos
ü El acrónimo CHARGE describe un síndrome polimalformativo congénito que incluye coloboma (C), malformaciones cardíacas (H), atresia de coanas (A), retraso psicomotor y/o en el crecimiento (R), hipoplasia de genitales (G), malformaciones auriculares y/o sordera (E)
ü La manifestación oftalmológica más frecuente son los colobomas coriorretinianos y/o papilares bilaterales (Imagen A y B). También pueden presentar afectación corneal secundario a una parálisis facial y fotofobia secundario a los colobomas del iris. Estos ojos suelen ser microftálmicos y suelen asociar defectos de refracción de fotma frecuente
ü Pueden evolucionar con desprendimiento de retina cuando coexiten colobomas coriorretinianos y papilares
Imágenes

ü La coroideremia es una degeneración progresiva del epitelio pigmentario retinal (EPR), de la retina y de la coroides con herencia recesiva ligado al cromosoma X y que afecta casi siempre a los hombres.
ü Se debe a una mutación del gen CHM
ü Es una entiedad clínica bien diferenciada que representa la distrofia coroidea hereditaria más frecuente en los países occidentales
ü La afectación de los fotorreceptores de la periferia media, sobre todo los bastones, es más precoz y acusada. Posteriormente se produce una atrofia progresiva que se extiende hasta el polo posterior
ü Presentan un moteado pigmentado con atrofia focal del EPR
ü Al avanzar la enfermedad, las áreas de atrofia coroidea dejan en descubrierto los vasos coroideos, quedando solo pequeñas zonas dispersas de la coroides intacta en la mácula y la periferia (Imagen A y B)
ü En la autofluorescencia las áreas de atrofia del EPR se ven como regiones hipoautofluorescentes rodeadas en ocasiones de un anillo de señal aumentada (Imagen C y D)
ü Los cambios en el OCT de mácula se reflejan con pérdida del epitelio pigmentario de la retina y coroides subyacentes con solo una pequeña isla de retina externa residual en la fóvea. (Imagen E y F)


ü El albinismo ocular es un trastorno ligado al cromosoma X en el que los hombres afectados presentan una producción anómala de melanina dentro del ojo
Clínica
ü Biomicroscopía: Transiluminación de iris
ü Fondo de ojo hipopigmentado con vasos coroideos fácilmente visibles, ausencia del brillo foveal (Imagen A)
ü OCT: se hace evidente la hipoplasia foveal (Imagen B).
ü Tambien pueden presentar nistagmo, error refractivo alto y decusación de fibras quiasmáticas aumentada.


ü 11 años, M.
ü Consulta porque “se acerca mucho a las cosas y además no ve de noche”
ü Sin antecedentes mórbidos conocidos.
ü Ex. Físico destaca
ü AV 20/50 OD y 20/50 OS cc
ü Refracción -10.0 esf/ +3.0 cyl x 100º OD; -10.75esf/+2.25cyl x 70º OI
ü Nistagmo, exoforia
ü BMC: normal
ü FO: Hipopigmentación del fondo de ojos + ausencia de brillo foveal
ü OCT: Hipoplasia foveal

ü La patogenesis de la MFNR no ha sido totalmente elucidada ü Estudios histologicos muestran áreas de mielinización de las fibras del nervio, células circundantes que son morfológicamente muy similares a los oligodendrocitos. Sin embargo, las fibras nerviosas retinales cubiertas por mielina están separadas y no directamente conectadas a las fibras desmielinizadas del nervio óptico
ü LA MFNR aparerece como parches estriados, blanco o blanco grisáceos con los bordes imprecisos y plumosos a menudo distribuido alrededor o contiguos al disco óptico y rodeando las arcadas vasculares (Imagen A y B)
ü En diversos estudios la MFNR ha sido localizadda más comúnmente en la región peripapilar superior (Imagen A y B)
Imágenes aportadas por Dra. Isabel Cavieres


Name:
ID:
DOB:
Gender:
Technician:
ALVAREZ ARRIAGADA, JUVENAL
Exam Date:
Exam Time:
Serial
Tecnologos,
Signal Strength:




ü Las fosetas congénitas de la cabeza del nervio óptico son una entiedad poco frecuente que afecta a <1 en 10.000 personas
ü Se desconoce la patogenia
ü Fue descrita por Wiethe como una depresión de color grisáceo en la cabeza del nervio óptico secundaria al cierre imperfecto de la fisura embrionaria
ü Se trata de invaginaciones intrapapilares de color gris perlado, de un tamaño comprendido entre 0.1 y 0.7 diámetros papilares y recubiertas de material glial pálido
ü Suelen localizarse en el margen del disco óptico que se ve frecuentemente distorsionado y resaltado por leves cambios del epitelio pigmentario retinal (EPR)
ü La mayoría son unilaterales (90%) y suelen ubicarse a nivel temporal
ü En un 25-75% de los casos pueden presentar desprendimiento seroso macular, que se presenta entre la segunda y cuarta década
ü Puede ser asintomática o causar una disminución de la agudeza visual debido principalmente a la maculopatía serosa
ü OCT se puede observar separación de las capas internas de la retina, y en ocasiones de desprendimiento seroso tambien se pueden evaluar por este método

Caso aportado por Dr. Nathan Dukes
ü Hombre 9 años es derivado al Hospital Calvo Mackena por cuadro de 4 años de disminución de la agudeza visual asociado a una exodesviación progresiva de ojo derecho.
ü A la biomicroscopía destaca:
- Xantocoria (Imagen A)
- Acúmulos densos de fibrina en vítreo (Imagen B y C)



ENFERMEDAD DE COATS
ü Malformación vascular no hereditaria, de etiología desconocida.
ü Epidemiología
-Unilateral 95%
-Hombres jóvenes/mujeres (3:1)
ü Rojo pupilar: Xantocoria
ü Fondo de ojo:
- Exudación
- Desprendimiento de retina
- Desarrollo anormal de vasos retinales: micro y macro aneurismas, telangectasias y dilatación capilar.
ü Etapificación
1 Telangectacia retinal (T)
2 Telangiectasia + exudación (E)
3 T+ E + Desprendimiento de retina exudativo (D)
4 T+E+D+ glaucoma (G)
5 T+E+D+G+ Ptisis bulbi (P)
ü Diagnóstico diferencial
-Retinoblastoma
-Desprendimiento de retina
-Enfermedad de Norrie
-Vitreo persistente hiperplásico primario
-Toxocariasis ocular
-Hemangiomatosis capilar retinal
-Hemangiomatosis cavernosa retinal
-Tumor vasoproliferativo
-Vitreorretinopatía familiar exudativa.

OJO DERECHO (Imagen D y E)
ü Desprendimiento de retina exudativo en polo posterior con compromiso macular
ü Acúmulos densos de fibrina en vítreo
ü Pigmento retinal inferior (cicatricial)
ü Exudados retinales duros
ü Malformaciones vasculares periféricas (telangectasias) en relación a exudados
ü Papila normal
ü Turbidez vitrea, múltiples membranas
OJO DERECHO (Imagen F)
8. COATS
Caso aportado por Dr. Nathan Dukes

Dü Vítreo turbio, membranas y pseudomembranas, algunas con adherencia al polo posterior.
ü Desprendimiento de retina en región macular con marcada respuesta inflamatoria subretinal.
ü Lesion subretinal temporal, irregular, heterogénea con cierto grado de reacción granulomatosa
ü No se observa reacción granulomatosa a nivel coroideo, sin coroideos
ü Coroiditis difusa.


Múltiples lesiones hiperpigmentadas de hipertrofia congénita del EPR (CHRPE) en la retina de un paciente de 55 años de edad.
ü La CHRPE es una lesion benigna
ü La CHRPE solitario se cree que es congénito, la edad promedio al diagnóstico es > 45 años
ü La CHRPE solitario puede parecer similar al melanoma y al nevo coroideo.
ü Su carácter asintomático justifica el diagnóstico tardío a pesar de que en algunos casos se pueden detectar defectos leves del campo visual
ü La CHRPE se ha relacionado con el síndrome de Gardner

C

ü CHRPE múltiple o bilateral puede ocurrir en la poliposis adenomatosa familiar (PAF)
ü La prevalencia de CHRPE en la población normal está entre el 1,2% y el 4,4%
ü Clínicamente aparece como una placa de fondo de ojo plana o mínimamente elevada bien delimitada, generalmente con lagunas despigmentadas típicas localizadas en el fondo de ojo periférico medio o periférico
ü En la tomografía de coherencia óptica (OCT) es típico el adelgazamiento de la retina suprayacente, la pérdida de fotorreceptores y el sombreado relativo moderado de la coroides subyacente
ü En la angiografia con fluoresceina se aprecia una hipofluorescencia, se cree que estos cambios vasculares son secundarios a una concentración excesiva de oxígeno en las capas internas de la retina que daría lugar a un daño vascular
ü EN la autofluorescencia se aprecia una hipoautofluorescencia debido a la disminución de la lipofuscina dentro de las células del EPR agrandadas densamente y pigmentadas uniformemente
Guedes G, Motesdeoca B, López C.. Congenital Hipertrophy of the retinal pigment epithelium (CHRPE): diagnosis and management. Sociedad Canaria de oftalmología.
Imágenes aportadas por Dr. Yuri Mercado




ü El edema de papila es el único signo clínico objetivo de hipertensión intracraneana (HIC) junto a cefalea y vómitos explosivos, por lo que es de gran importancia reconocerlo
Manifestaciones clínicas del edema papilar precoz
ü Hiperemia, que es uno de los primeros signos en aparecer
ü Borramiento de los bordes de la papila, primero el borde nasal, luego los polos y por último el borde temporal
ü Solevantamiento de la papila sobre el plano retinal
ü Borramiento de vasos finos del borde de la papila
ü Aparición de fenómenos vasculares como engrosamiento de venas, hemorragias y exudados Diagnóstico
ü Lo más importante es el aspecto clínico, pero puede haber casos dudosos
ü Ante la duda y un paciente con buen estado general, se puede controlar a los 7 días, si el paciente sigue agravar sus signos, se seguirá controlando
ü En el EP verdadero se observará una evolución hacia la progresión
ü Si al inicio hay síndrome de HIC y compromiso del estado general, se debe evaluar al paciente en conjunto con neurólogo y neurocirujano y se pedirán estudios de imágenes (TC, RNM)
Luco C, Fernández V, Trigo C, Amaya N, Peña L. Papila Óptica. Curso de Neuroftalmología. 2019
Imagen aportada por Dr. Nathan Dukes

A. Quiste dermoide
B. Xantelasma
C. Hidrocistoma
D. Chalazion
E. Hemangioma cavernoso
F. Cuerpo cutáneo
A. Melanoma palpebral
B. Carcinoma escamoso
C. Carcinoma escamoso
D. Carcinoma basocelular
4. SÍNDROME BLEFAROFIMOSIS – PTOSIS – EPICANTO INVERSO
A. Celulitis orbitaria complicada con un absceso orbitario
B. Dacriocistitis
C. Compromiso ocular por mucormicosis


Epidemiología


ü Los tumores orbitarios en niños son poco frecuentes, siendo el quiste dermoide el más común, constituyendo del 3-9% de las masas orbitarias.
ü En el caso de los adultos es poco frecuente y cuando se presenta, típicamente se asocia a un traumatismo.
Histología
ü Son coristomas.
ü Son usualmente redondas, de paredes bien definidas y contienen apéndices cutáneos incluyendo folículos pilosos, glándulas sudoríparas y sebáceas.
Clínica
ü Se presenta clásicamente como una masa en la órbita superotemporal o superonasal a lo largo de las líneas de sutura cigomático-frontal o fronto-etmoidal.
ü Pueden volverse sintomáticas por efecto de masa dependiendo de la localización, generando proptosis, desplazamiento del globo ocular y diplopia.
ü En caso de ruptura, el paciente puede evolucionar con inflamación marcada y posterior fibrosis de tejidos adyacentes

ü Imagen : xantelasmas del parpado superior de ojo izquierdo.
ü Los xantelasmas corresponden a patología benigna.
ü Histológicamente son macrófagos cargados de lípidos en la dermis superficial o tejido subdérmico.
ü Clínicamente son placas amarillentas planas que habitualmente se ubican en el canto interno de los párpados o en párpado superior. Pueden ser únicas o múltiples.
ü En ocasiones se asocian a cuadros de dislipidemias adquiridos o congénitos por lo que pueden requerir control y seguimiento.
ü Se pueden extirpar, remover con ácido tricloroacético o con ablación con laser.
Imágenes aportadas por Dr. Benjamín Riesco y Dr. María José Vergara A


ü Imágenes A y B corresponde a hidrocistomas de parpado inferior de ojo derecho, en canto medial.
ü Imagen C, hidrocistoma de canto medial de parpado superior ojo izquierdo. .

Hidrocistoma ecríno
ü Tumoración quística benigna de los párpados de las glándulas sudoríparas.
ü Se presentan con mayor frecuencia en mujeres de edad media.
ü Habitualmente pequeños. Pueden ser múltiples y estar asociados a hiperhidrosis.

Aü Mujer de 28 años cursando su primer trimestre de embarazo consulta por aumento de volumen localizado en varias zonas de ambos ojos asociado a eritema. La paciente refiere que drenan líquido purulento cuando se ducha.
ü Imagen A y B muestra un chalazión en parpado superior, tercio medio y signos de blefaritis en parpado inferior.
Caso aportado por Dra. María José Vergara

ü Chalazión corresponde a una lesión inflamatoria lipogranulomatosa crónica estéril que reside dentro del párpado y que se debe a la obstrucción de las glándulas de meibomio.
ü Condición común que puede estar asociada a rosácea y blefaritis crónica.
ü Tratamiento agudo: calor local, masajes y colirio mixto (antibiótico + corticoides).
ü El manejo crónico es curetaje y biopsia en casos de recidiva o aspecto sospechoso.

ü Imagen A aumento de volumen de párpado inferior ojo derecho.
ü Imagen B secuencia T2 flare de resonancia de orbita. Se observa aumento de volumen hiperintenso medial a globo ocular.

ü EL hemangioma cavernoso orbitario constituye una tumoración vascular benigna de crecimiento lentamente progresivo.
ü Es una malformación vascular caracterizada por la presencia de sinusoides de paredes finas, que contienen colecciones hemáticas sin flujo arterial o venoso aparente.
ü Corresponde al tumor orbitario primario más frecuente del adulto (4-12.8%).
ü Afecta principalmente entre los 40-50 años, mayormente a mujeres.
ü Ubicación intraconal es la más frecuente.
ü Clínicamente se presenta como ptosis unilateral o exoftalmo lentamente progresivo e irreductible, de crecimiento indoloro.
ü Unifocal es lo mas común. Casos multifocales pensar en síndrome nevo azul.
ü Imágenes: en RM se observa masa encapsulada que indenta el globo ocular, hipointensa en T1 e hiperintensa en T2.
ü Tratamiento conservador si es asintomático. Resección quirúrgica en casos sintomáticos.

ü Imagen corresponde a ojo izquierdo que presenta cuerno cutáneo en párpado superior en la unión del tercio medio con tercio externo.
ü Diagnóstico clínico
ü Lesión de hiperqueratosis exuberante
ü Se presenta en pacientes añosos
ü Pueden originarse de queratosis seborreica, verruga vulgar o carcinoma espinocelular.
ü El manejo actual corresponde a biopsia excisional de base de la lesión, con base relativamente amplia. Apuntes

ü Imágenes de melanoma en el margen palpebral del parpado inferior tercio medio. Lesión pigmentada adquirida de bordes rregulares con un grado variable de ulceración central, que provoca depresión de párpado inferior.
ü Presentación infrecuente, corresponde al 1% de los tumores malignos de párpados.
ü Los parpados pueden ser un lugar de ubicación de melanomas de forma primaria o extensión desde la región malar.
ü Sospechar ante cambios de pigmentación, forma, tamaño, consistencia y plano de piel que lo rodea.
ü Tipos de melanoma:
ü Extensión superficial 70%
ü Lentigo maligno 4- 15%
ü Acral 2-8%
ü Nodular 10-15%



ü Imágenes A, B y C muestran tumor exofitico de Hombre de 75 años.
ü El carcinoma escamoso de la conjuntiva (CEC) es el tumor maligno más frecuente de la superficie ocular, presentando una incidencia que va desde 0,13 a 1,9 por 100.000 habitantes.
ü La invasión intraocular y orbitaria constituye solo un 212% del total de casos.
ü El CEC afecta principalmente entre los 50 y 75 años, mayormente hombres y se asocia a la exposición solar.
ü Clínicamente se presenta como una lesión unilateral, asintomática, de progreso lento y de carácter exofítico, sésil o pedunculado; gelatinoso, con vasos superficiales que suelen afectar la región interpalpebral cerca del limbo esclerocorneal, pero puede afectar a cualquier zona del globo ocular.
ü Hombre de 93 años derivado por cuadro de 1 año de evolución caracterizado por una lesión conjuntival exofítica que evoluciona comprometiendo la totalidad del globo ocular izquierdo e invadiendo estructuras post septales (Imagen A).
ü Es evaluado por el equipo de orbita del hospital del Salvador quienes solicitan biopsia que confirma el diagnóstico de CEC.


En este caso como tenía presencia de compromiso

la exanteración orbitaria fue el tratamiento estándar.
TAC (Imagen B y C) : Lesión conjunctival expansiva orbitaria izquierda , con aumento de volumen y extension post septal
ü Lesión eritematosa de bordes solevantados nodulares, con ulceración central que altera la arquitectura del borde palpebral, generando un ectropión mecánico con mayor compromiso medial.
ü El carcinoma basocelular es la lesión maligna más común de los párpados, con un 90-95% de frecuencia y tiene diferentes presentaciones clínicas; nodular, ulcerativa, pigmentada y morfeaforma.
ü La forma nodular es la más frecuente, característicamente redondeado, perlado, con telangectasias, seguido por las formas ulcerativas, nódulos ulcerativos o multicéntricos.
ü Ubicación en orden de frecuencia se presentan en canto medial 48.3%, párpado inferior 47.5% y párpado superior 3.9%.
ü Factor de riesgo principal es la exposición UV, con mayor impacto si es durante las primeras 2 décadas de vida. Este riesgo aumenta si esta asociado a hábito tabáquico y antecedente de carcinoma basocelular previo.
ü Su origen es la capa basal de la epidermis.
ü Son de crecimiento lento y el tarso constituye una importante barrera, pero pueden ser invasivos y presentar metástasis en un 0.1%
1. Apuntes del Módulo Oculoplástica del “CURSO DE FORMACIÓN Y PERFECCIONAMIENTO DE OFTALMÓLOGOS” año 2020 de la Sociedad Chilena de Oftalmología.
2. American Academy Of Ophthalmology Basic and Clinical Science Course 2019-2020. Book 7 Oculofacial Plastic and Orbital Surgery. Chapter 11 Classification of Eyelid Disorders

ü Imagen corresponde a ojo derecho que presenta ojo rojo con vasos conjuntivales y subconjuntivales dilatados, en tirabuzón.
ü
Malformación vascular simple de alto flujo.
ü En general se presentan post traumatismos graves que provocan una conexión súbita entre arteria carótida y seno cavernoso.
ü Clínica:
ü Exoftalmo pulsátil
ü Ojo rojo, con gran congestión conjuntival.
ü Vasos en tirabuzón
ü Frémito ocular
ü Soplo ocular
Imágenes aportadas por Dr. Yuri
Mercado

ü El síndrome Blefarofimosis-ptosis-epicanto inverso (BPES) es una enfermedad genética rara, la prevalencia, aunque no ha sido evaluada de forma precisa, es probablemente menor de 1:5,000.
ü Este síndrome es causado por variantes heterocigóticas del gen forkhead box L2 (FOXL2).
ü Muestra herencia autosómica dominante pero también puede ocurrir esporádicamente.
ü Según la mutación, se han descrito dos subtipos fenotípicos, ambos con las mismas características craneofaciales: el tipo I, que se asocia con insuficiencia ovárica prematura (POF), y el tipo II, que no tiene características sistémicas.
ü BPES está caracterizado por blefarofimosis (reducción general de la abertura palpebral), ptosis, telecanto (incremento de la distancia entre los ángulos internos del ojo) y epicanto inverso (piel plegada y elevada del párpado inferior que se extiende hacia arriba, revistiendo parcialmente el ángulo ocular interno).
ü Otras manifestaciones oftálmicas que pueden asociarse con BPES incluyen párpados displásicos, anomalías del conducto lagrimal, estrabismo, defectos de refracción, ambliopía y un desplazamiento lateral del punto lagrimal inferior.
ü Otras características craneofaciales pueden incluir un puente nasal ancho y orejas de implantación baja.
Caso











ü La celuilitis preseptal (celulitis periorbitaria) es la infección del párpado y la piel periocular por delante del tabique orbitario.
ü La celulitis orbitaria es la infección de los tejidos orbitarios por detrás del tabique orbitario.
ü Ambos tipos de celulitis pueden ser causados por un foco externo de infección (p. ej., una herida), por infecciones que se extienden desde los senos nasales, los dientes, o por diseminación metastásica de infecciones en otras partes del cuerpo.
ü Los síntomas incluyen dolor, eritema y edema palpebral; la celulitis orbitaria también suele causar fiebre, malestar general, exoftalmía, deterioro de la movilidad ocular y alteraciones visuales.
ü El diagnóstico se basa en la anamnesis, la exploración y la TC o la RM.
ü El tratamiento se hace con antibióticos y a veces, con drenaje quirúrgico.
Caso aportado por Dr. Osvaldo Weisse y Dra. María José Vergara











ü Hombre de 30 años sin antecedentes consulta en policlínico del Hospital del Salvador por cuadro de 1 día de evolución caracterizado por aumento de volumen palpebral, eritema, calor local izquierdo asociado a dolor a los movimientos oculares.
Al examen físico
ü AVà OD:1,0 /OI: LMP
ü PIOà OD: 12/ OI:44
ü RFMà + en OD/ Alterado (DPAR+) OI
ü Motilidad Ocular: restricción a la motilidad OI (Imágenes)
ü BMCà OD normal / OI: quemosis 360º, Pupila semimidriasis, resto Normal. (imágenes)
Manejo
ü Hospitalizar
ü Cantotomía – Cantolisis
ü Drenaje quirúrgico
ü Ceftiaxona EV + Clindamicina EV ü TAC de orbita
ü Exámenes de laboratorio
Caso aportado por Dr. Osvaldo Weisse y Dra. María José Vergara

Orbita derecha:
ü De aspecto conservado Órbita izquierda

ü Masa de partes blandas mal definida con compromiso pre y post septal, con compromiso extraconal en su segmento medial e inferior que contacta los musculos rectos medial e inferior ü Tejido adiposo intra y extraconal de densidad normal ü Las paredes orbitarias de características conservadas ü Agujeros ópticos, fisura orbitaria superior e inferior de aspecto normal
EXÁMENES DE LABORATORIO: destaca leucocitosis 12.430 sin desviación a izquierda, VHS 75 y PCR 97,6

EXPLORACIÓN QUIRÚRGICA + CANTOTOMÍA - CANTOLISIS ü Abordaje transconjuntival inferior, con drenaje de abundante secreción purulenta. Se realiza aseo + inserción de drenaje penrose por orbitotomía transconjuntival inferotemporal ü Cantotomía + Catolisis


ü Imagen A.
Dacriocistitis aguda: En el canto medial derecho a nivel del saco lagrimal se aprecia un aumento de volumen eritematoso además de una zona central pustulosa. Alrededor de la lesión hay bordes eritematosos que se extienden comprometiendo párpado superior e inferior lo cual impide la apertura ocular.
ü Imagen B. Dacriocistitis crónica: aumento de volumen en el canto medial izquierdo, en relación a la ubicación del saco lagrimal.
ü Dacriocistitis aguda es un cuadro infeccioso del saco lagrimal, que evoluciona en horas a días y se presenta con epifora, tumoración inflamatoria, edema, eritema y dolor.
ü Microrganismos mas frecuentes corresponden a gram positivos, Staphylococcus aureus y Staphylococcus epidermidis.
ü Diagnóstico diferencial con picadura de insectos, tumor maligno saco lagrimal, celulitis orbitaria, sinusitis y linfoma orbitario.
ü Las complicaciones son abscesos (23%), fistulas (5.6%), celulitis orbitaria (2.8%) y con menor frecuencia trombosis del seno cavernoso.
ü TAC de orbita ayuda con: el diagnóstico diferencial, evaluar complicaciones, variaciones anatómicas, fracturas antiguas, patologías nasales y para planificar una futura cirugía, una dacriocistorrinostomía.
ü Las dacriocistitis crónicas se caracterizan por epifora, conjuntivitis crónica, ojo congestivo con secreción y reflujo de pus al presionar el saco lagrimal.
Caso



ü Paciente 70 años con antecedentes de diabetes miellitus tipo II es ingresada a la UTI por cuadro compatible con cetoacidosis, además destaca la presencia de aumento de volumen periocular y ausencia de movimientos oculares por lo que deciden realizar interconsulta a oftalmología.
ü Imágenes A y B muestran signos de eritema y edema palpebral superior e inferior unilateral de ojo izquierdo. En imagen B se aprecia quemosis.
ü Imagen C, placa grisácea en paladar que corresponde a lesión necrótica de mucosa.

Dü Imagen D: Tomografía de orbita que destaca ocupación y velamiento de seno etmoidal izquierdo.

ü Imagen E: Placa necrótica de mucosa nasal vista endoscópica.
ü Paciente es tratada con resección quirúrgica + anfotericina B liposomal sin buena respuesta, falleciendo a la semana.
Mucormicosis corresponden a un cuadro de infecciones fúngicas letales y necrotizantes, con destrucción tisular de mucosa nasal, especialmente cornete medio, etmoides y paladar. La mucormicosis se debe sospechar ante:
• Celulitis orbitaria de evolución rápida: quemosis, proptosis, disminución de agudeza visual, oftalmoplejia y dolor facial desproporcionado.
• Mala respuesta a tratamiento antibiótico.
• Factores de riesgo: diabetes descompensada, cetoacidosis, neoplasias hematológicas, inmunosupresión por VIH, trasplante, uso de corticoides, gran quemado, etc.
• Presencia de síntomas y signos de compromiso del estado general y/o síntomas neurológicos y pulmonares.
• Signos de trombosis de vena oftálmica y/o trombosis de seno cavernoso.
ü Forma rinocerebral es la mas frecuente.
ü Mortalidad de 40-80%.
ü Pilares de tratamiento:
• Revertir inmunosupresión o cetoacidosis.
• Tratamiento micótico lo mas pronto posible: anfotericina B liposomal o liofilizado.
• Desbridamiento quirúrgico.
A. Cuerpo extraño encapsulado
B. Rotura de membrana de descemet por forceps
C. Iridodiálisis e iridotomía traumática – Infiltrados subepiteliales por adenovirus
D. Catarata traumática
E. Luxación de catarata intumescente
F. Núcleo de catarata traumática luxada a cámara anterior
G. Catarata subluxada
H. Subluxación de lente intraocular (LIO)
I. Luxación de lente intraocular a cámara vítrea
J. Hifema traumático
K. Hifema traumático + Fibrina en cámara anterior
L. Enfisema subconjuntival
M. Filtración C3F8 subconjuntival
N. Conmoción retiniana
O. Conmoción retiniana – Diálisis retiniana
P. Coriorretinopatía esclopetaria
Q. Hemorragia subhialoidea
R. Silicona en cámara anterior
A. Herida penetrante ocular + cuerpo extraño intraocular
B. Herida penetrante ocular + cuerpo extraño intraocular
C. Herida penetrante ocular + Cuerpo extraño intraocular
D. Herida penetrante ocular + Cuerpo extraño intraocular
E. Herida penetrante ocular + catarata traumática
3. HERIDA PÁRPADO INFERIOR
En 1996, Kuhn y otros propusieron una terminología específica del trauma ocular con la finalidad de estandarizar la denominación de las lesiones, es así como se denominó:
ü Lesión con globo ocular abierto: aquella que compromete todo el espesor de la pared. Dentro de estas clasificación forman parte:
- Rotura (estallido) ocular
- Herida penetrante ocular
- Cuerpo extraño intraocular
- Herida perforante ocular
ü Lesión con globo ocular cerrado: aquella que no compromete todo el espesor de la pared. Dentro de esta clasificación forman parte
- Contusión ocular
- Laceración lamelar
- Erosiones
- Cuerpo extraño superficial
Sin embargo esta clasificación excluye el compromiso de párpados y anexos

Caso aportado por Dra. María José Vergara
ü Hombre 40 años con antecedente de cuerpo extraño hace 6 meses acude a la Unidad de Trauma Ocular consultando por lesión blanquecina en el ojo.


ü Imagen A, B y C: Cuerpo extraño encapsulado



ü La rotura de la membrana de Descemet se produce típicamente cuando una de las palas de los fórceps se ajusta sobre el reborde orbitario inferior y comprime el globo ocular contra el techo de la órbita.
ü El anillo de Schwalbe, en el límite de la membrana de Descemet es relativamente inelástico, siendo el origen de las roturas de la membrana de Descemet. Así, la compresión en sentido infero-superior produce un acortamiento de este eje corneal, con lo que el diámetro horizontal se agranda, originando la rotura de la membrana Descemet vertical, asociándose invariablemente a la alteración endotelial subyacente.
ü Así, aunque existen descritas roturas de la membrana de Descemet horizontales asociadas al empleo de fórceps, la orientación más habitual es vertical u oblícua .
Imágenes aportadas por Dr. Nathan Dukes
üLa iridodiálisis no es más que la separación de la raíz del iris del cuerpo ciliar como resultado de un trauma ocular a globo cerrado en este caso.
üLa iridotomía traumática es una abertura traumática en el iris, que deja en comunicación la cámara anterior y la posterior del ojo.
üAdemás este paciente presentaba infiltrados subepiteliales por adenovirus (información descrita en el capítulo de cornea)
Şengül Ö, Mehmet Cüneyt Ö. A Simple Surgical Technique for Repair of Iridodialysis. Turk J Med Sci. 2009;39(2):317-9



Caso aportado por Dr. María José Vergara y Dr. Pablo Inostroza


ü Hombre 30 años recibe golpe en ojo izquierdo durante una riña
ü Catarata traumática en roseta
ü iridodiálisis
ü Ruptura zonular

üLa catarata traumática es la opacificación del cristalina como consecuencia de un traumatismo, el cual puede provocar la ruptura de la cápsula o comprometer el parenquima. Este evento traumático puede ser ocasionado por factores mecánicos y por factores no mecánicos. Dentro de los factores mecánicos se encuentran: trauma ocular a globo cerrado (contuso), trauma ocular a globo abierto (penetrante, perforante, cuerpo extraño intraocular o mixto). En los factores no mecánicos se incluyen las drogas, sustancias químicas, como ácidos o álcalis. También se encuentran en este subgrupo las radiaciones ultravioletas, microondas, láser, energía térmica o eléctrica.
üEl aspecto más característico de una catarata traumática por contusión es la forma en roseta, localizada en la parte anterior, posterior o ambas de la cápsula y puede aparecer después de ocurrida la lesión o transcurrir meses o años en completarse la opacidad.
RAMOS PEREIRA, Yanay; GUERRA GARCÍA, Roberto Alejandro. Afecciones traumáticas del cristalino y de la lente intraocular. Revista Cubana de Oftalmología, [S.l.], v. 25, feb. 2013. ISSN 1561-3070.
ü Hombre sufre trauma ocular contuso hace 1 año, hace 3 meses con dolor, asociado a ojo rojo.
ü

Imagen A y B: fotografías de segmento anterior, visión anterior y lateral de luxación de catarata intumescente hacia inferior asociado a compromiso corneal. A
üEl cristalino luxado o subluxado constituye el desplazamiento del cristalino de su posición normal, asociado a una debilidad o rotura zonular.
üSe puede clasificar en parcial cuando es una subluxación y en total cuando el cristalino se desplaza a la cámara anterior, al vítreo o al espacio subconjuntival.
üLa subluxación o luxación del cristalino se generan en traumatismos graves por la onda de presión hacia adelante o hacia atrás generada por la contusión.

BüEl mecanismo de subluxación también puede producirse hacia delante más frecuente en fáquicos y hacia atrás en cavidad vítrea más frecuente en pseudofáquicos.
üLos principales síntomas que caracterizan a esta entidad son: miopía lenticular, astigmatismo, el efecto del borde lenticular y la diplopía monocular. También son frecuentes signos como la iridodonesis, facodonesis, cámara anterior irregular y en ocasiones vìtreo en cámara anterior.
üSi existe luxación a cámara anterior pude producirse un bloqueo pupilar y daño corneal endotelial. De ocurrir una luxación a vítreo se comporta como un afáquico, pudiendo provocar hipertensión ocular, e incluso bloqueo pupilar.
1. RAMOS PEREIRA, Yanay; GUERRA GARCÍA, Roberto Alejandro. Afecciones traumáticas del cristalino y de la lente intraocular. Revista Cubana de Oftalmología, [S.l.], v. 25, feb. 2013. ISSN 1561-3070. 2. Santos- Bueso E, Sáenz - Frances F, Díaz-Valle D, Troyano J, López-Abad C, Benítez- del Castillo JM, García -Sánchez J. Estallido ocular con luxación de cristalino al espacio subconjuntival. Arch Soc Esp Oftalmol,Imágenes aportadas por Dr. Tomás Gonzalez

ü Luxación de catarata traumática a cámara anterior
ü
Quemosis hemorrágica

ü Luxación de catarata traumática a cámara anterior asociado a edema corneal
Caso aportado por Dr. Nathan Dukes



ü Hombre 51 años con antecedentes de trauma ocular contuso hace 24 años en ojo derecho, comienza hace 2 meses con ojo rojo derecho, lo cual hace 1 mes se asocia a dolor ocular progresivo.
AV OD
ü NPL
PIO OD
ü 40
Biomicroscopía
ü Semimidriasis
ü Tyndall +++
ü Catarata subluxada
Gonioscopía
ü Ángulo en 2 cuadrantes
ü Neovascularización angular
ü Semimidriasis
ü Vitreo
ü Catarata subluxada
ü Tyndall
ü Catarata subluxada


Imagen aportado por Dr. Matías
Ramírezü Imagen A y B: fotografías de segmento anterior que muestran luxación de complejo saco mas lente intra ocular (LIO), luxado hacia camara anterior capturado en el iris, secundario a contusión ocular, trauma ocular cerrado
üEl desplazamiento del lente intraocular después de la cirugía, incluso dentro de su cápsula, puede ocurrir por la rotura zonular o por un sosporte capsular insuficiente.
üEste evento ocurre frecuentemente secundario a trauma contuso.
üPuede producir síntomas de miopía lenticular, astigmatismo, efecto del borde lenticular y diplopia monocular.
üLos principales signos son iridodonesis, camara anterior irregular, visualización del borde o háptica del LIO. En ocasiones se observa una prominencia vítrea en cámara anterior e hipertensión ocular secundaria a un bloqueo pupilar.
RAMOS PEREIRA, Yanay; GUERRA GARCÍA, Roberto Alejandro. Afecciones traumáticas del cristalino y de la lente intraocular. Revista Cubana de Oftalmología, [S.l.], v. 25, feb. 2013. ISSN 1561-3070.
Caso aportado por Dra. María José Vergara

ü Hombre 75 años consulta por disminucón súbita de AV del ojo izquierdo hace 3 meses tras golpe con puño.
ü LIO luxado a cámara vítrea


Bü Hifema traumático se define como la presencia de sangre en cámara anterior.
ü Su incidencia es de 17/100.00 habitantes/años, siendo más frecuente en pacientes jóvenes, y sexo masculino.
ü Mecanismo: Accidente laboral, pistolas de juguetes, agresiones, accidente de tránsito, actividades deportivas y castigo corporal.
Clasificación según cuantía
ü Microhifema: Tyndall hemático ü Grado:
I. <1/3 de cámara anterior (CA)
II. 1/3-1/2 de CA
III. >1/2 de CA
IV. Hifema total

ü Mujer 60 años refiere golpe con pelota en ojo izquierdo por lo cual consulta en unidad de trauma ocular.
ü En la imagen A y B observamos quemosis en 360ª asociado a presencia de sangre en cámara anterior que ocupa alrededor de 1/2
Gragg J, Blair K, Baker MB. Hyphema. In: StatPearls. Treasure Island (FL): StatPearls Publishing; 2020.Caso aportado por Dra. María José Vergara



Complicaciones del hifema traumático:
ü Hipertensión ocular ü Resangrado ü Hematocórnea
ü Sinequias
ü Recesión agngular
Factores de mal pronóstico visual del hifema traumátocp ü Edad >15 ü AV >= PL
ü Resangrado ü HTO
ü Daño colateral: Cristalino, cuerpo ciliar, retina, etc
La imagen A, B y C trata de un paciente de 14 años que consulta dos días posterior a un golpe en ojo derecho.
En la página siguiente describiré los hallazgos. A B C
Caso aportado por Dra. María José Vergara

ü Quemosis en 360º
ü Dilatación farmacológica
ü Fibrina en cámara anterior
ü Hifema organizado





Dü El enfisema subconjuntival se define como la presencia de aire subconjuntival.
ü EL enfisema subconjuntival es una entiedad poco frecuente que ocurre tras el paso de aire desde la cavidad nasal o senos paranasales al espacion subconjuntival.
ü La mayoria de los casos se relacionan con traumatismo directo en la cavidad ocular, fractura etmoidal y en la mitad de ellos, con fractura de estructuras orbitarias.
ü Imágenes A, B, C y D corresponden al ojo derecho de un hombre de 45 años que sufrió una fractura de pared medial de la órbita, evolucionando con enfisema subconjuntival del ojo derecho.
üLa aplicación de gas C3F8 es una técnica muy difundida para el bloqueo de lesiones retinianas pequeñas, por su versatilidad, rápida absorción y pocos efectos secundarios.
üPor tratarse de gas expansible es recomendable que las esclerotomías en la cirugía de retina sean
bloqueadas perfectamente y evitar al máximo los esfuerzos del paciente, pues el gas puede difundirse rapidamente a los tejidos orbitarios y a nivel subconjuntival si encuentran una vía de salida.
Presentamos las imágenes de un hombre de 30 años que sufre trauma ocular contuso. Al exámen oftalmológico destaca iridodialisis y desprendimiento de retina. Por lo anterior se decide realizar vitrectomía con aplicación de gas C3F8. Al control post operatorio presenta filtración de C3F8 subconjuntival.


Blanco A, Camacho C, Hernández A, Zapata R, Huerta A. Enfisema orbitario por gas perfluoropropano posterior a cirugía de retina. Informe de un caso. Rev Med Inst Mex Seguro Soc 2010; 48 (3): 321-324 A
Imagen A:
üQuemosis conjuntival 360ª
üIridodiálisis
Imagen B: üFiltración C3F8 subconjuntival




ü Se caracteriza por la presencia de una opacidad transitoria visible mediante oftalmoscopía, de coloración blanco grisácea, confinada a la retina sensorial externa, dentro del polo posterior o la periferia retiniana.
ü Cuando la conmoción está confinada al polo posterior (edema de Berlín) puede observarse una mancha rojo cereza en la fóvea, similar a la que ocurre en presencia de una oclusión de la arteria central de la retina.
ü Las lesiones presentan una morfología geométrica, con márgenes frecuentemente mal definidos, los vasos retinianos se ven claramente y parecen no estar alterados.
ü Además, pueden asociarse hemorragias (sub, intra y prerretinianas), roturas coroideas y desprendimientos serosos de retina.
ü La conmoción retiniana suele resolverse espontáneamente sin dejar secuelas, con retorno de la agudeza visual a niveles pretraumáticos; no obstante pueden aparecer hiperplasia y/o atrofia del epitelio pigmentario de la retina (simulando un cuadro de retinitis pigmentosa) y agujeros maculares.
1. Gass JDM. Stereoscopic Atlas of Macular Diseases: Diagnosis and Treatment. 4a Ed, 1997 (St Louis, Mosby)
JV, Foos RY, Heckenlively J.Traumatic Pigmentary Retinopathy. 92 (Am J Ophthalmol 1981), pp. 621-624
J, Chen S. Contusion Injuries and Their Ocular Effects. 84 (Clin Exp Optom 2001), pp. 19-25


Conmoción retiniana (descrita en imagen anterior)
Diálisis retiniana
ü Pueden originarse bruscamente sobre una retina sana a continuación del traumatismo que comprime el globo en sentido anteroposterior, aunque pueden llegar a tardar semana o meses en aparecer cuando responden a una tracción vitreorretiniana.
ü Se trata de una desinserción de la retina en la ora serrata.
ü La localización más frecuente es temporal inferior o nasal superior. ü Muchas son silentes o se pueden presentar con borrosidad ligera de la visión, miodesopsias o fotopsias.
1. Pita, D. (1994). Diccionario terminológico de oftalmología. Madrid, España: IM&C. 69, 78, 79, 138, 140, 144, 160, 173, 179, 180.
2. Ruiz, R. y Domingo, M. L. (1994). Traumatología ocular. (I) Contusiones oculares. En: Clement F. Oftalmología. España: Luzán. pp 473-484. 3 Pacheco, P y Capeans, C (1998) Desprendimiento de la Retina traumático En: Capeans C desprendimientote La Retina y Vitreorretinopatíaproliferante. Allergan. Pp 187-228.


ü Mujer 37 años, luego le disparan con escopeta en OI el 20/06/2019.
AV OI
ü OI CAE: 0.1p
Exámen externo izquierdo (sin imágenes disponibles)
ü Herida de borde palpebral inferior a temporal. Equimosis conjuntival inferotemporal Biomicroscopía OI
ü Sin alteraciones
Fondo de ojo OI
ü Desgarro patrón esclopetario
Por lo anterior se solicita un TAC en donde se aprecian múltiples CE orbitarios en OI.
ü La CRE se refiere a la rotura simultánea de la retina y coroides resultante de un trauma causado por un proyectil de alta velocidad que hubo pasado adyacente para entrar en contacto con el globo ocular, entrando a la órbita sin causar ruptura escleral. La simultánea retracción de la retina y la coroides revela una esclerótica sin daño.
ü El vítreo puede ser claro o hemorrágico. Hay hemorragias coroideas y retinianas extensas. La esclera aparece intacta y, a menudo, el examinador puede ver la presencia de tejido fibroso proliferativo blanco y la alteración pigmentaria asociada. Hemorragias intraoculares agudas resultan de la ruptura de los vasos coroideos y retinianos causada por las fuerzas de conmoción directa del proyectil.
1. Papakostas T, Yonekawa Y. Traumatic chorioretinal ruptura (sclopetaria). International Ophthalmology Clinics. 2013; 53 (4): 119-125.
2. Fraser E, Haug S. Clinical presentation of chorioretinal sclopetaria. Retinal Cases & Briefs Reports. 2014; 8 (4): 257-259.
3. West CE, Meisels AA et al. Chorioretinitis sclopetaria. Am J Ophthalmol. 1968; 66 (5): 852-860.
4. Ahmadabadi M, Karkhaneh R. Clinical presentation and outcome of chorioretinitis sclopetaria: a case series study. Injury Int J Care Injured. 2010; 41: 82-85.
5. Igal V, Igal Y, Pikkel Y. Chorioretinitis sclopetaria-Case report. Case Reports in Ophthalmology. 2017; 1-4.


ü Estos pacientes tienen una baja posibilidad de desprendimiento de retina. Los hallazgos periféricos de la ruptura traumática coriorretiniana son una manifestación de trauma directo; la disrupción del área macular también puede ocurrir como resultado de un trauma de contragolpe indirecto generado por la fuerza de conmoción del proyectil que hubo pasado cerca del globo ocular.
ü La energía de estas fuerzas es proporcional al tamaño y la velocidad del proyectil y puede ser lo suficientemente significativa como para causar una ruptura coroidea y macular. En las lesiones más graves, puede haber afectación periférica y macular, con peor pronóstico para la recuperación visual. En general, la agudeza visual se relaciona con la extensión y la ubicación de la ruptura coriorretiniana; la mala agudeza visual presenta un peor pronóstico visual para el paciente.
1.
2.
3. West CE, Meisels AA et al. Chorioretinitis sclopetaria. Am J Ophthalmol. 1968; 66 (5): 852-860.
4. Ahmadabadi M, Karkhaneh R. Clinical presentation and outcome of chorioretinitis sclopetaria: a case series study. Injury Int J Care Injured. 2010; 41: 82-85.
5. Igal V, Igal Y, Pikkel Y. Chorioretinitis sclopetaria-Case report. Case Reports in Ophthalmology. 2017; 1-4.
Papakostas T, Yonekawa Y. Traumatic chorioretinal ruptura (sclopetaria). International Ophthalmology Clinics. 2013; 53 (4): 119-125. Fraser E, Haug S. Clinical presentation of chorioretinal sclopetaria. Retinal Cases & Briefs Reports. 2014; 8 (4): 257-259.Imagen aportada por Dr. Álvaro Rodríguez y Dr. Villarroel


ü Imágenes A y B: retinografías de ojo izquierdo que muestran gran lesión hemorrágica con un nivel y forma de ovalada hacia el interior de la cavidad vítrea contenida por la membrana limitante interna. En imagen C se observa parte del contenido hemorrágico cayendo en la cavidad vítrea.

ü “Retinopatía hemorrágica de Valsalva” resulta de la rotura de los capilares retinianos superficiales asociada con una elevación aguda de la presión venosa ocular tras actividades típicas como levantar objetos pesados, toser, vómitos, etc. Esto ocurre debido a la ausencia de válvulas en el sistema venoso de la cabeza y el cuello que permiten la transmisión de la presión torácica o abdominal al ojo.
ü Característicamente se observa elevación roja en forma debajo de la membrana limitante interna en o cerca de la mácula central. Ocasionalmente, irrumpe hasta el espacio subhialoideo o la cavidad vítrea.
ü Frecuentemente las hemorragias se resuelven y la visión vuelve a la normalidad. Por lo que el manejo habitual es la observación. De lo contrario se puede realizar vitrectomía y en algunos casos el drenaje de la hemorragia al vítreo mediante la rotura de la pared que la mantiene con láser Nd: Yag.
Caso aportado por Dr. María José Vergara
Hombre de 35 años que sufre trauma contuso. Al exámen oftalmológico destaca catarata traumatica y desprendimiento de retina. Por lo anterior se decide realizar facoaspiración + vitrectomía con aplicación de silicona. Al control post operatorio presenta burbuja de silicona en cámara anterior.


üBurbuja de silicona en cámara anterior
üDiscoria pupilar asociada a ruptura de esfinter pupilar
üFibrosis del saco
üInyección conjuntival
üBurbuja de silicona en cámara anterior
üFibrosis del saco

ü
Hombre 28 años mientras sacaba clavos de una madera le salta clavo a ojo derecho.
ü Cuerpo extraño metálico que atraviesa el espesor de la cornea pero sin llegar al iris.
ü El trauma causado por cuerpo extraño intraocular (CEIO) es un trauma penetrante con permanencia del agente agresor dentro del globo ocular.
ü Los CEIO constituyen hasta el 40 % de los traumas oculares a globo abierto. Afectan con mayor frecuencia a hombres jóvenes que están relacionados con algunos trabajos donde se martilla hierro sobre hierro, utilización de algunas maquinarias, disparos de armas de fuegos de proyectil o perdigones, o cerca de una explosión. Todos estos accidentes ocurren por la no utilización de medios de protección y las consecuencias a veces son devastadoras, por la pérdida del globo ocular, en ocasiones en individuos jóvenes y en edad laboral activa. 1.
Caso aportado por Dr. Andrés Torres

ü Paciente hombre mientras pescaba en el mar le cae anzuelo de compañero en el ojo derecho.
ü Imagen: Herida penetrante corneoescleral causada por anzuelo metálico.


ü Ruptura del esfinter iridiano
ü Laceración corneal coaptada
ü Hombre 35 años mientras esmerilaba le cae al ojo cuerpo extraño metalico que atraviesa la cornea, el esfinter iridiano y se aloja en el cristalino.
ü Laceración corneal coaptada
ü Inyección conjuntival
ü Cuerpo extraño intracristaliniano A

ü
Caso aportado por Dr. Álvaro Rodríguez
Hombre 27 años mientras esmerilaba le cae al ojo cuerpo extraño metalico que atraviesa la cornea, iris, cristalino y se aloja en la retina.




ü El 16% de los trauma oculares abiertos tienen cuerpo extraño intraocular (CEIO).
ü La causa más frecuente es el metal (martillar matal contra metal)
ü Más prevalente en hombres jóvenes
ü En el acercamiento inicial a este tipo de pacientes es importante conocer el mecanismo de lesión, composición del CEIO, ubicación y riesgo de infección.
ü Junto con el equipo de retina se debe evaluar extracción de cuerpo extraño metalico intraretinal.
Caso aportado por Dr. Álvaro Rodríguez


Imagen A
üPigmento en Cápsula anterior
üQuemosis conjuntival 360ª
üHerida penetrante iridiana
üHerida penetrante corneal
Imagen B: sección óptica de la córnea fotografiada lateralmente
üHerida penetrante iridiana
üHerida penetrante corneal
Caso aportado por Dr. Álvaro Rodriguez


Imagen C: üRotura de la capsula anterior (Herida penetrante cristalienana)
Imagen D
üEl cuerpo extraño metalico probablemente golpeó la retina en la parte inferior (donde se ve edema de retina, algo de esclera desnuda y hemorragia)
üPaciente 35 años le cae cuerpo extraño metálico al ojo, el cual atraviesa espesor corneal, la cápsula anterior, el cristalino, cápsula posterior


AüQuemosis conjuntival en 360º
Catarata traumática
üRuptura capsula anterior
üMasas libres
ü Herida penetrante corneal
üAumento de grosor corneal secundario a edema corneal
ü Paciente hombre se cae en el bosque enterrándose palo de madera en ojo derecho.


ü Palo de madera extraído de párpado inferior.
üQuemosis conjuntival en 360º
Palo de madera en párpado inferior
üHerida párpado inferior sin compromiso de vía lagrimal
